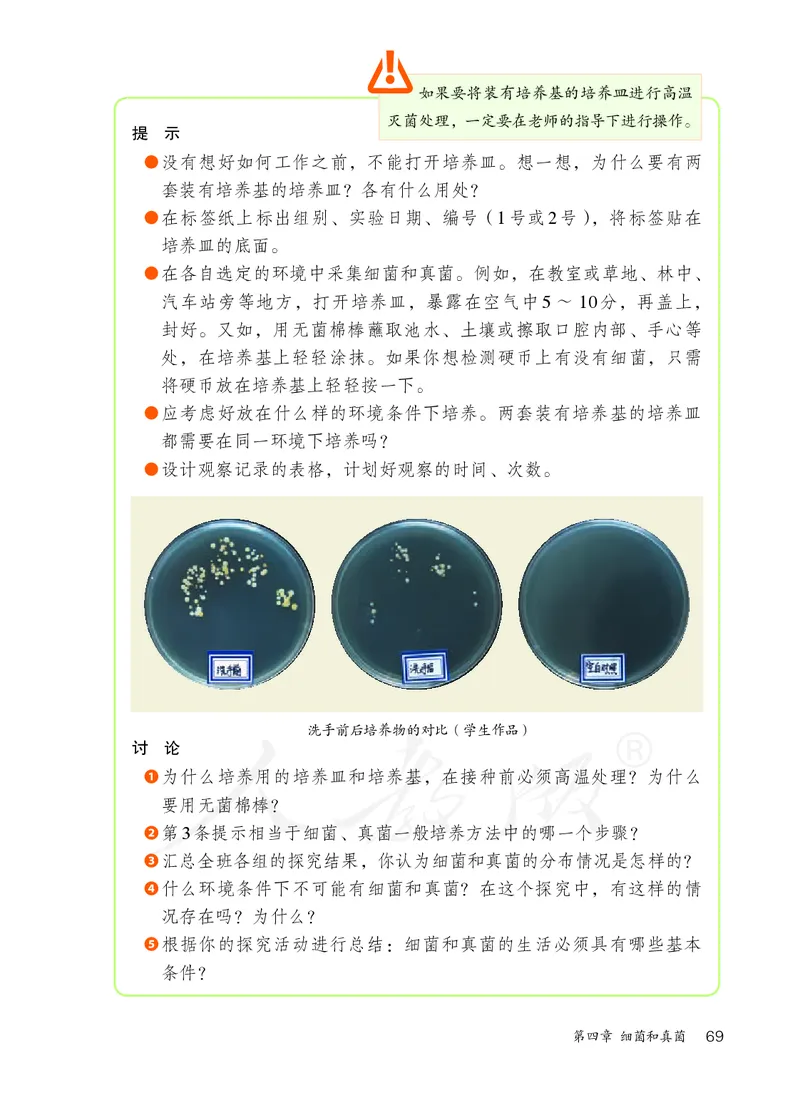
初中二年级上册生物_教资初高中_教资面试2025教资面试备考资料合集_教资面试资料合集_3、教资面试资料包大全_45大圣中小幼面试资料包_初中_生物_初中生物电子课本

文档内容
® YIWU JIAOYU JIAOKESHU
SHENGWUXUE 义
务
八年级
教
全国优秀教材二等奖
育
教
科
义务教育教科书
上册
书
生物学 八年级 上册 封面动物/红松鼠
生
物
生物学
学
八
年
级
上
册
绿绿色色印印刷刷产产品品
初初中中封封面面生生物物学学88上上--环环境境标标 11 22002222//44//11 0099::1155义 务 教 育 教 科 书
生物学
八年级
上册
人民教育出版社 课程教材研究所
编著
生物课程教材研究开发中心
·北 京·主 编:朱正威 赵占良
主要编写人员:朱正威 张雁云 陈 香 王伟光 王真真 李 红 鲍平秋
周 然 李新花 张 怡 王 颖 吴成军 赵占良
责任编辑:陈 香 王 颖
美术编辑:王 喆
版式设计:李 猛(北京气和宇宙艺术设计有限公司)
插 图:王仿溪(封面) 文鲁工作室
图片提供:朱 京 张雁云 王 放 康 宁 徐 瀚 郭 耕 周 然
吕向阳 王德利 柴西勤 陈子豪 朱家祥 纪卫国
Albert Calbet Sara Zimorski the Jane Goodall institute
国家杂交水稻工程技术研究中心 中科院水生生物研究所等
义务教育教科书 生物学 八年级 上册
人民教育出版社 课程教材研究所
编著
生物课程教材研究开发中心
出 版
(北京市海淀区中关村南大街 17 号院 1 号楼 邮编:100081)
网 址 http://www.pep.com.cn
版权所有·未经许可不得采用任何方式擅自复制或使用本产品任何部分·违者必究
如发现内容质量问题,请登录中小学教材意见反馈平台:jcyjfk.pep.com.cn
如发现印、装质量问题,影响阅读,请与×××联系调换。电话:×××-××××××××目 录
第五单元 生物圈中的其他生物 ..............................................1
第一章 动物的主要类群 ........................................................................2
第一节 腔肠动物和扁形动物 .............................................................3
第二节 线形动物和环节动物 .............................................................8
第三节 软体动物和节肢动物 ...........................................................12
与生物学有关的职业 养殖专业户
..................................................18
第四节 鱼 .........................................................................................19
第五节 两栖动物和爬行动物 ...........................................................25
第六节 鸟 .........................................................................................30
生物学与艺术 动物与造型艺术
......................................................35
第七节 哺乳动物 ..............................................................................36
与生物学有关的职业 兽医师
.........................................................40
第二章 动物的运动和行为 ..................................................................41
第一节 动物的运动 ..........................................................................42
生物学与文学 借动物以言志
.........................................................46
第二节 先天性行为和学习行为 ........................................................47
科学·技术·社会 动物行为学家的新装备
....................................52
第三节 社会行为 ..............................................................................54
科学家的故事 珍妮·古道尔和黑猩猩交朋友
................................59
第三章 动物在生物圈中的作用 .........................................................61
科学·技术·社会 动物与仿生
......................................................65
第四章 细菌和真菌 ..............................................................................66
第一节 细菌和真菌的分布 ...............................................................66
目录 1第二节 细菌 .....................................................................................71
第三节 真菌 .....................................................................................75
第四节 细菌和真菌在自然界中的作用 .............................................79
科学·技术·社会 以菌治虫
.........................................................83
第五节 人类对细菌和真菌的利用 ....................................................84
科学·技术·社会 “超级细菌”近在咫尺
....................................88
第五章 病毒 ..........................................................................................89
科学·技术·社会 狂犬病和狂犬病病毒
.......................................93
第六单元 生物的多样性及其保护 ......................................95
第一章 根据生物的特征进行分类 .....................................................96
第一节 尝试对生物进行分类 ...........................................................96
第二节 从种到界 ...........................................................................101
科学家的故事 林奈和双名法
......................................................105
第二章 认识生物的多样性 ..............................................................106
第三章 保护生物的多样性 ..............................................................110
2 目录第五单元
生物圈中的其他生物
静谧的林边空地,
一洼清清的池塘。
大自然和谐的一角,
生活着多少生灵!
生产者、消费者、分解者,
谁能离得开谁!第一章
动物的主要类群
动物是多种多样的,你平时所看到的虫鱼鸟兽
都是动物。为什么说它们都是动物呢?也许你会
说,因为它们都能运动。其实,动物与植物还有一
个显著的区别:动物不能像植物那样通过光合作
用制造有机物,只能靠摄取食物来获得现成的有机
物,从而维持生存和繁衍(图5-1)。
动物是怎样发现和获取食物的?怎样尽量避免
被其他动物吃掉的?又是怎样生殖的?在不同类群
图5-1 鲣鸟捕鱼 的动物身上,你会发现各种精彩的答案。
2第一节 腔肠动物和扁形动物
想一想,议一议
固着在海中礁石上的海葵,乍一看宛如艳
丽的花朵,因此有人称之为“海中之花”。然
而,它们却不是植物,而是动物。那么,它们
是如何获取食物的呢?
腔肠动物
通过本节学习,你将知道:
海葵属于腔肠动物。腔肠动物的身体结构比 ◂ 腔肠动物和扁形动物的
较简单,其中大多数种类生活在海洋中,如水母、海 主要特征是什么?
◂ 它们与人类的生活有什
葵、海蜇、珊瑚虫等;少数种类生活在淡水中,如
么关系?
水螅(图5-2)。
海月水母 海蜇 水螅
图5-2 常见的腔肠动物
腔肠动物虽然形态各异,但它们的基本结构
是相似的。我们通过观察水螅,来了解它们的基
本特征。
水螅通常生活在水流缓慢、水草繁茂的清洁
淡水中。它的身体几乎透明,长约1厘米,一端附
着在水草等物体上,另一端有口,口周围伸展着
5~12条柔软细长的触手,用于探寻和捕获猎物。
第一章 动物的主要类群 3观察水族箱或烧杯中的水螅,看看它们的
身体结构有什么特点。用滴管吸取两三个活水
水蚤
蚤,在水螅正上方2厘米处,将水蚤从滴管中轻
轻推出,观察水螅的捕食过程(也可以观看水
螅捕食的录像)。
讨 论
❶ 水螅的身体能分出背面和腹面,左侧和右侧
水螅
吗?这样的体形与捕食有什么关系?
❷ 水螅怎样捕食水蚤?推测它是如何将水蚤消
化的?
水螅捕食水蚤
通过观察,可以发现水螅的身体只能分出上下,
分不出前后、左右和背腹,经过身体纵轴可以有多
个切面将身体分为对称的两部分,这种体形称为辐
射对称(radial symmetry)(图5-3)。由于水螅是附
着生活的,而猎物和捕食者可能来自各个方向,辐
射对称的身体结构,便于它感知周围环境中来自各
个方向的刺激,从各个方向捕获猎物、进行防御。
观察水螅的纵切面示意图(图5-4),可以看
到,水螅的身体由内外两层细胞——内胚层和外胚
层构成,这两层细胞中间填充着它们分泌的胶状物
质。内胚层细胞所围成的空腔叫作消化腔,消化腔
图5-3 水螅的身体呈辐射对称 与口相通,吃进去的食物就在腔内被内胚层细胞消
化,消化后的食物残渣仍从口排出。外胚层有多种
细胞,如刺细胞。刺细胞是腔肠动物特有的攻击和
防御的利器,在触手处尤其多。
其他腔肠动物在身体结构、捕食、防御等方面
与水螅相似,它们的主要特征是:身体呈辐射对
称;体表有刺细胞;有口无肛门。
4 第五单元 生物圈中的其他生物触手
图5-4 水螅的纵切面示意图
水螅的刺细胞里大多藏着刺丝
和毒液。当遇到猎物或捕食者
时,水螅能迅速弹出细长而中
空的刺丝,并将毒液通过刺丝
注入猎物或捕食者体内,将其
麻醉或杀死。
卷曲的刺丝 口
内胚层
猎物
外胚层
消化腔
弹出的刺丝
芽体
(芽体长成小水螅后,就会从
细胞核
刺细胞 母体上脱落下来,独立生活)
腔肠动物中,海蜇经加工后可以食用,具有较
小资料
高的营养价值;珊瑚虫分泌的石灰质物质,堆积构
2011年2月发表
成了珊瑚礁(图5-5),如澳大利亚的大堡礁。我
的一份名为《珊瑚礁
国的南海诸岛,有许多是珊瑚礁形成的。珊瑚礁不
危险再现》的报告
仅可以形成岛屿、加固海岸,还为海底的鱼类等海 指出,全世界有75%
的珊瑚礁正在受到威
洋生物提供了重要的栖息场所和庇护地。然而,由
胁。
于过度采挖、环境污染以及全球变暖等原因,珊瑚
礁破坏严重,珊瑚虫大量死亡,导致许多海洋生物
失去了庇护所。让我们爱护这美丽的珊瑚礁吧! 图5-5 珊瑚虫形成的珊瑚礁
5
5眼点
扁形动物
在清澈溪流中的石块下面,有时会发现一类
身体背腹扁平、形状像柳叶的动物,它们的体长
背面
为1 ~ 1.5厘米,背面呈褐色,三角形的前端背面
有两个可以感光的黑色眼点。它们就是涡虫(图
口 5-6),属于扁形动物。
咽
涡虫的口长在腹面,口内有一个管状的咽。咽
腹面
肠
可以伸出口外,捕食水中的小动物。吃进去的食物
在肠内消化,消化后的食物残渣仍从口排出,有口
无肛门。
图5-6 涡虫结构示意图
由图5-7可以看出,涡虫的身体呈两侧对称
(bilateral symmetry),也称左右对称,就是经过身
体的纵轴只有一个切面将身体分为对称的两部分。
绝大多数动物的身体都呈两侧对称,两侧对称的动
物,身体可以分出前后、左右、背腹,前端(头
部)感觉器官集中,能够最先感知外界刺激,使身
体定向运动,身体的两侧或腹面通常有专门的运动
器官。这样的体形使运动更加准确、迅速而有效,
有利于动物捕食和防御。
扁形动物中像涡虫这样自由生活的种类很
少,大多数扁形动物寄生在人和动物体内,如华
图5-7 涡虫的身体呈两侧对称
枝睾吸虫(图5-8)、血吸虫、绦虫。这些寄生虫
(parasite)的消化器官很简单,有的甚至没有专门
的消化器官,靠获取寄主体内的养料生活,而它们
子宫
的生殖器官却特别发达,如华枝睾吸虫就因精巢发
达、呈树枝状而得名。华枝睾吸虫通常先寄生在纹
沼螺等淡水螺中,然后进一步感染草鱼、鲫鱼等淡
卵巢
水鱼以及虾类,人或动物若是食用了生的或未煮熟
精巢 的含有该吸虫的鱼虾,就会被感染。在我国南方部
分地区流行的血吸虫病是由日本血吸虫感染引起的
(图5-9),人若是进入含有钉螺的水域,很可能被
图5-8 显微镜下的华枝睾吸虫
(装片经染色) 感染。
6 第五单元 生物圈中的其他生物雌虫
1.生活在人体
内的成虫交配、
5.幼虫从钉螺
雄虫 产卵。
体内逸出,进
入水中,钻入
人体皮肤,在
人体内发育为
成虫。
幼虫 卵
2.虫卵随粪便排
出,在水中孵
化成幼虫。
4.幼虫在钉螺体内
钉螺
繁殖,并进一步发育。
幼虫
3.幼虫钻入钉螺体内。
小资料
图5-9 日本血吸虫感染人的过程 血吸虫的卵和幼
虫非常微小,通常需
要借助显微镜等工具
进行观察。
扁形动物的主要特征是:身体呈两侧对称;背
腹扁平;有口无肛门。
练习
1. 把符合下列动物类群特征的选项填入括号内。
腔肠动物( ) 扁形动物( )
A. 没有肛门; B. 有刺细胞; C. 大多数种类身体扁平;
D. 部分种类没有专门的消化器官; E. 身体呈辐射对称。
2. 如果一条小溪原来可以采集到水螅,现在却采集不到,你认为最可能的原
因是什么?
3. 有些人喜欢吃生鱼片等食物,你认为不将鱼煮熟直接食用是否安全?为什么?
第一章 动物的主要类群 7第二节 线形动物和环节动物
想一想,议一议
你知道蛔虫病吗?蛔虫寄生在人 雄虫
体的什么器官内?为什么儿童容易得
蛔虫病?
雌虫
线形动物
通过本节学习,你将知道:
◂ 线形动物和环节动物的 线形动物因体形细长如线而得名,有些是自由
主要特征是什么? 生活的,有些寄生在人、家畜、家禽和农作物的体
◂ 它们与人类的生活有什
内。蛔虫是常见的线形动物。
么关系?
蛔虫寄生在人的小肠里,靠吸食小肠中半消化
的食糜生活。它的身体呈圆柱形,前端有口,后端
有肛门;体表包裹着一层角质层,起保护作
用;消化管的结构简单,肠仅由一层细胞
口 组成,可消化小肠中的食糜;生殖器官发
达,生殖能力强(图5-10)。蛔虫没有专
门的运动器官,只能靠身体的弯曲和伸展缓
肠 慢地蠕动。
雌雄蛔虫在人的小肠中交配后,雌
虫产下的大量的虫卵随人的粪便排出体
外。人喝了带有虫卵的生水,吃了沾有
生殖器官 虫卵的生的蔬菜,或者用沾有虫卵的
手去拿食物,都可能感染蛔虫病。因
此,预防蛔虫病,首先必须注意个人
肛门
饮食卫生,不喝不清洁的生水,蔬
菜、水果要洗干净,饭前便后要洗
手;其次,要管理好粪便,粪便要
图5-10 蛔虫结构示意图(雌虫)
经过处理杀死虫卵后,再作肥料使用。
雌虫长20~35厘米,雄虫比雌虫略短。
除了蛔虫,线形动物还包括蛲虫、
8 第五单元 生物圈中的其他生物钩虫、丝虫、线虫(图5-11)等。它们的主要特征
是:身体细长,呈圆柱形;体表有角质层;有口有
肛门。
秀丽隐杆线虫是自由生活的线形动物。它长约
1毫米,全身透明,容易繁殖,生活周期短,是人
类研究遗传、发育、衰老等过程的重要实验动物。
环节动物 图5-11 显微镜下的秀
丽隐杆线虫
雨后,有时可以见到蚯蚓在地面上爬行。蚯蚓
(图5-12)的身体也是细长的,但是它却不属于线
形动物,而是环节动物。蚯蚓为什么被称为环节
动物?它的身体结构有什么特点呢? 前端
环带 图5-12 蚯蚓
观察蚯蚓
目的要求
观察蚯蚓的外部形态及运动。
材料用具
活蚯蚓、糙纸、棉球、放大镜。
方法步骤
(1)观察蚯蚓的外部形态。
❶ 取一条活蚯蚓,观察它的体形,想一想,怎样区别它的前端和后端,
背面和腹面,左侧和右侧?注意观察它的身体是否分节。辨认蚯蚓
的前端,数数从蚯蚓的前端到环带共有多少节。
❷ 用手指从前到后、从后到前触摸蚯蚓腹面,你有什么感觉?用放大
镜观察,你会发现蚯蚓的大多数体节都有一圈或几圈小突起,这些
小突起就是刚毛,刚毛朝向身体的后方。
第一章 动物的主要类群 9(2)观察蚯蚓的运动。
将蚯蚓放在糙纸上,观察它的运动,注意其身体粗细及长短的变
化。想想这些变化是怎样发生的?
(3)用手触摸蚯蚓,能不能感觉到它的体表有黏液?
注意:在观察过程中,应经常用浸水的湿棉球轻擦蚯蚓体表,使它
的体表保持湿润。
!
讨 论
实验后,别
❶ 蚯蚓的身体是否呈两侧对称?
忘了将蚯蚓放归
❷ 身体分节对于运动有什么意义?刚毛在运动
自然环境中。
中起什么作用?
❸ 体表黏液有什么意义?在实验过程中为什么
要使蚯蚓体表保持湿润?
通过观察,可以发现蚯蚓的身体呈长圆筒形,
小资料
由许多相似的环形体节构成。蚯蚓身体的前部有几
繁殖期间,环带
个体节界限不明显,颜色也与其他体节不同,而且
上的腺细胞分泌蛋白
比其他体节厚,如同在蚯蚓的身体上戴了一个环,
质和黏液,形成一个
套在环带外面的蛋白 称为环带。
质环。蛋白质环会带
身体分节可以使蚯蚓的躯体运动灵活。蚯蚓的
着1〜3个受精卵从蚯
体壁有发达的肌肉,肌肉与刚毛配合可以完成运
蚓身体上脱落,形成
动。肠壁也有发达的肌肉,肠可以蠕动。蚯蚓在土
卵茧。受精卵在卵茧
内发育为小蚯蚓。 壤中钻来钻去,以土壤中的有机物为食。
蚯蚓体壁可以分泌黏液,使体表保持湿润。蚯
蚓体壁密布毛细血管,氧气可溶于体表的黏液里,
然后进入体壁的血管中,体内的二氧化碳也经体壁
的毛细血管由体表排出。
沙蚕(图5-13)、蛭(图5-14)也属于环节动
物,它们的身体结构与蚯蚓相似。环节动物的主要
特征是:身体呈圆筒形,由许多彼此相似的体节组
成;靠刚毛或疣足辅助运动。
10 第五单元 生物圈中的其他生物图5-13 沙蚕 图5-14 吸附在人皮肤上的蛭
沙蚕生活在海洋中,身体由许多相似的体节组 蛭生活在水田、沟渠、池沼或潮湿的丛林中,
成,体节两侧均有突起,突起上有刚毛,这些 可通过吸盘吸附在鱼、蛙、家畜以及人的皮肤
突起称为疣足,可用于爬行和游泳。 上,吸食血液。
沙蚕是鱼、虾、蟹的食饵。蛭的唾液中有防止
血液凝固的物质——蛭素,在医学上可以利用提取
到的蛭素,生产抗血栓药物。蚯蚓对人类的益处更
多。它在土壤中活动,疏松土壤;它吃进土壤中的
有机物,消化后排出的粪便中含有丰富的氮、磷、
钾等养分,能够提高土壤肥力;它的身体富含蛋白
质,是优良的蛋白质饲料。
练习
1. 判断下列说法是否正确。正确的画“√”,错误的画“×”。
(1)线形动物都是寄生的。 ( )
(2)蚯蚓的运动是仅靠刚毛完成的。 ( )
2. 以下动物中, 属于环节动物, 属于线形动物。
A. 蛔虫; B. 蚯蚓; C. 小麦线虫; D. 丝虫; E. 蛭; F. 沙蚕。
3. 如何区别某个动物是环节动物还是线形动物?
4. 雨后,蚯蚓往往会爬到地面上来,这是为什么?如果农田中的蚯蚓消失了,
农作物的生长会不会受到影响?为什么?
第一章 动物的主要类群 11第三节 软体动物和节肢动物
想一想,议一议
你你喜喜欢欢右右图图中中的的贝贝壳壳吗吗??长长有有这这些些贝贝壳壳
的动物是什么样子的?坚硬的贝壳会妨碍它们的运动吗?
软体动物
通过本节学习,你将知道:
◂ 软体动物和节肢动物的 “想一想,议一议”中说到的这些动物,贝壳
主要特征是什么? 内的身体非常柔软,因而称之为软体动物。目前已
◂ 它们与人类的生活有什
命名的软体动物有10万种以上,是动物界的第二
么关系?
大类群。
河蚌、扇贝、文蛤、缢蛏等是我们熟悉的软体
动物,它们的外面有两片大小相近的石灰质贝壳,
因而称为双壳类。壳内柔软的身体表面包裹着犹如
外套一般的肉质膜,称为外套膜(mantle),贝壳
(shell)就是由外套膜分泌的物质形成的。
贝壳
取一只双壳类动物(如河
外套膜
蚌、扇贝、文蛤、缢蛏等),打
开贝壳后,揭开部分外套膜,
对照右图,观察内部结构。
讨 论
❶ 贝壳的作用是什么? 鳃
出水管
❷ 你所观察的动物是靠什么结
入水管
构运动的?又是靠什么结构
呼吸的呢?
❸ 试着想一想,它是如何获取
缢蛏的内部结构(揭开部分外套膜) 足
食物的?
12 第五单元 生物圈中的其他生物双壳类动物可以用足缓慢地运动,通过身体后
端的入水管吸入水,水流经身体一些器官后,再通
过出水管排出体外。在吸入和排出水的过程中,摄
取水中的食物颗粒并排出未消化的残渣,同时,利
用鳃(gill)与水流进行气体交换。
除了双壳类动物,软体动物还有很多,如石
鳖、蜗牛、乌贼(图5-15)。它们的主要特征是:
柔软的身体表面有外套膜,大多具有贝壳;运动器
官是足。
漏斗
石鳖 蜗牛 乌贼
石鳖背部有8个呈覆瓦状排 蜗牛的壳为螺旋形,依靠 乌贼身体内有退化的贝壳,
列的贝壳,身体腹面有一 大而扁平的足来爬行,足 有一对发达的眼,10条腕
个扁平的足,可用足在岩 内腺体会分泌黏液,可减 足用于捕食,可借助漏斗
石表面缓慢爬行或吸附在 少爬行时足与地面的摩擦 喷水的反作用力快速运动。
岩石上。 力,头部有触角、眼等感 遇到敌害时能喷出墨囊里
觉器官。 的墨汁,掩护逃生。
图5-15 几种软体动物
软体动物中有很多成为人工养殖的对象。中国 小资料
是水产养殖大国,水产养殖总量名列世界第一,其 河蚌的外套膜受
到沙粒等异物的刺激
中贝类产量也位居世界首位。牡蛎、扇贝、鲍等富
时,会分泌大量的珍
含蛋白质和多种维生素,且脂肪含量低。鲍的壳
珠质把异物层层包裹
(石决明)、乌贼的壳(海螵蛸)、珍珠粉可入药, 起来,最后形成了珍
螺壳和珍珠是很好的装饰品。不过,有些软体动物 珠。珍珠与贝壳内表
面的成分相同,主要
也对人类有一定危害。例如,钉螺是日本血吸虫的
成分为碳酸钙。
中间寄主,与血吸虫病的传播有关。
第一章 动物的主要类群 13节肢动物
说起节肢动物,你可能觉得很陌生,事实上,
你经常能见到它们。你可能在实验中接触过鼠妇,
它就属于节肢动物。树枝上的鸣蝉,草丛里的蟋
蟀,花丛中的蝴蝶,房檐下的蜘蛛,石块下的蜈
蚣,以及虾、蟹、蚊、蝇等,都属于节肢动物。节
肢动物是最大的动物类群,目前已命名的种类有
120万种以上,占所有已知动物种数的80%以上。
观察蝗虫(或蝉)、七星瓢虫(或蜻蜓)、
蜘蛛、蜈蚣、虾(或蟹)等动物,若无活体,
也可观察标本或下面的图片。
14 第五单元 生物圈中的其他生物讨 论
❶ 比较你所观察的动物的形态结构特征,完成下面的表格。
动物名称
体表是否较硬
身体是否分节,
不同体节有无差别
有无触角,触角是否分节
有无翅
有几对足,足是否分节
❷ 上表中哪些动物的形态结构比较相似?试着说说它们的共同特征。
❸ 你能归纳出表格中所有动物的共同特征吗?
通过上面的活动,你会发现蝗虫、七星瓢虫等
动物的形态结构相似,它们都属于昆虫(insect)。昆
小资料
虫是节肢动物中种类最多的一类动物。现在,我们
昆虫的复眼由许
以蝗虫为例来认识昆虫。
多小眼组成,在视觉
蝗虫身体分为头部、胸部和腹部三部分(图
上起主要作用,而单
5-16)。头部负责感觉和摄食,感觉器官有一对触 眼仅能辨别明暗。
角,三个单眼和一对复眼,口器用于摄食。胸部是
触角
腹部 胸部 头部
单眼
复眼
口器
翅
后足
中足 前足 图5-16 蝗虫示意图
气门
第一章 动物的主要类群 15? 运动中心,有三对足,善于跳跃;有两对翅,适
于飞行。触角和足等是昆虫的附肢,分节。腹部
附肢分节对于昆虫有
集中容纳内脏器官。此外,体表有气门,用于呼
什么意义?
吸。用手触摸蝗虫的身体,能感觉到它的体表比较
硬,那是因为在它的身体表面包着坚韧的外骨骼
(exoskeleton)。
昆虫身体上的外骨骼不仅是能保护自己的“盔
甲”,还能起到防止体内水分蒸发的作用,但外骨
骼会限制昆虫的发育和长大,所以昆虫需要定期蜕
皮(图5-17)。昆虫一生中蜕皮的次数一般是固定
的,通常发育为成虫后就不再蜕皮。
由上可知,昆虫的基本特征包括:有一对触
蝉蜕
角、三对足,一般有两对翅,等等。
通过前面的活动,你会发现,虽然蜘蛛看起来
很像昆虫,但是它有4对足用于爬行,没有翅,也没
有触角,因此不属于昆虫。虾、蜈蚣等动物也不是
昆虫,但是这些动物都具有一些相同的特征:体表
具有外骨骼,身体和附肢都分节。因此,它们都属
于节肢动物,节肢动物就因附肢分节而得名。
通过比较这些动物的形态结构特征,我们
可以看出,节肢动物的主要特征是:体表有坚
韧的外骨骼;身体和附肢都分节。
节肢动物与人类的关系非常密切。虾、蟹等
为人类和其他海洋生物提供了动物蛋白。蜜蜂等
昆虫为地球上几十万种开花植物传播花粉。蝎、
蜈蚣、蝉蜕等可以入药,治疗疾病。果蝇是非常
经典的实验材料(图5-18),许多重要科研成果
都与这种小小的昆虫分不开。但是,有不少节肢
动物也给人类带来诸多困扰,例如,蚊、蜱、螨
叮咬人,并传播疾病。
图5-17 昆虫的蜕皮(蝉)
16图5-18果蝇
果蝇主要以腐烂的水果为食,
是遗传学中常用的实验动物。
练习
1. 判断下列说法是否正确。正确的画“√”,错误的画“×”。
(1)软体动物都生有贝壳。 ( )
(2)节肢动物的附肢分节,身体不分节。 ( )
2. 下列关于动物的生活环境及获取食物的方式的叙述中,正确的是:( )
A.腔肠动物生活在水中,利用刺细胞帮助捕获猎物;
B.寄生虫终生生活在寄主体表或体内,靠获取寄主体内的养料生存;
C.软体动物生活在水中,靠入水管、出水管获取水里的食物颗粒;
D.节肢动物生活在陆地上,利用口器获取食物。
3. 用线将以下动物类群与对应的特征连接起来。
腔肠动物 身体扁平,有口无肛门
扁形动物 身体分节,运动器官为刚毛或疣足
线形动物 身体表面有外套膜
环节动物 身体和附肢都分节,有外骨骼
软体动物 身体表面有刺细胞
节肢动物 身体不分节,体表有角质层
4. 软体动物的贝壳与昆虫的外骨骼,对动物生存的意义有什么相同和不同之
处?
5. 在所有的动物类群中,节肢动物的种类和数量是最多的,想一想这与它们
的哪些特征有关呢?
第一章 动物的主要类群 17养殖专业户
你知道吗?许多农民靠养殖经济
动物走上了致富的道路,养牛蛙的,
养鳖的,养獭兔的,养黑貂的……下
面介绍一位靠养蝎致富的阿姨,她的
名字叫王素燕。
王素燕高中毕业后,因家中困难,
没能圆大学梦。她从报纸杂志和电视上
搜集有关致富的信息。1986年,她选准
了投资少、销路好的全蝎养殖项目,于
是说服家人,贷款购买了种蝎和饲料,
办了一个养殖场。经过十多年的发展,
她的养殖场发展成为规模很大的养殖公司,经济效益十分可观。
谈起多年的养蝎之路,王素燕感慨颇多。开始养殖时,因为不太了
解蝎的生活习性,饲养方法不当,一冬过后,有很多种蝎死亡。她带着
死蝎找专家请教。专家说:这是蝎子的“春亡关”,国内人工养蝎业迄
今还没有很好的解决方法。王素燕不肯认输,暗下决心,一定要闯过这
一关。她走访了上百个养蝎人,还拜科研单位的生物学专家为师,学习
动物学知识,终于解决了蝎的“春亡关”问题。
二龄幼蝎的蜕皮难是制约养蝎业发展的又一道难题。许多养蝎户的
二龄蝎在蜕皮时死亡率在70%以上。为了攻克这道难关,王素燕和技术
人员,吃住在蝎棚内,不分昼夜地观察记录,苦思对策,终于解决了这
个难题,养蝎的效益大大提高。
你的家乡有养殖专业户吗?如果有,建议你去他们的养殖场走访,
问问他们在养殖过程中遇到过什么问题,他们是怎么解决这些问题的。
从与他们的交谈中,你可能会得到一些启示。
(本文系根据刘兵正《从农家女到女经理——记华北“女蝎王”王素
燕》一文改编。)
18 第五单元 生物圈中的其他生物第四节 鱼
想一想,议一议
右图所示的是鲫鱼的骨骼。
脊柱
观察它的脊柱和组成脊柱的一节
节的脊椎骨。
哪些动物是有脊柱的?哪些
动物是没有脊柱的?脊柱与鱼的
运动有关吗?
通过前面三节的学习,你已经认识了很多种动
通过本节学习,你将知道:
物,它们的体内没有由脊椎骨组成的脊柱,统称为 ◂ 鱼的主要特征是什么?
无脊椎动物(invertebrate)。后面将要讨论的鱼、 ◂ 鱼与人类的生活有什么
两栖动物、爬行动物、鸟和哺乳动物,它们的共同 关系?
特点是身体内都有由脊椎骨组成的脊柱,统称为脊
椎动物(vertebrate)。
多种多样的鱼
小资料
鱼(fish)是脊椎动物中种类最多的一个类群,
现存的动物已知
占脊椎动物种类的一半以上。它们有的生活在浩瀚
的有150多万种,其
的海洋中,有的生活在河流、湖泊和池塘等淡水水
中无脊椎动物约占
域;有的在水体上层游动,有的在水体底部栖息; 95%,脊椎动物约占
5%。
有的以藻类等水生植物为食,有的生性凶猛,专门
捕食其他水生动物(图 5-19)。
我国有着漫长的海岸线、众多的江河湖泊,因
此,鱼的种类十分丰富。据调查,我国淡水鱼有
1 000多种,如著名的“四大家鱼”(青鱼、草鱼、
鲢鱼、鳙鱼)和鲤鱼、鲫鱼等;我国的海洋鱼已
知的约有2 000种,常见的有带鱼、大黄鱼、小黄
鱼、鳓鱼、鲳鱼、鲐鱼、鲅鱼、大麻哈鱼、鲚鱼、
鲥鱼等。
第一章 动物的主要类群 19背鳍
图5-19 多种多样的鱼 侧线 淡水鱼
鲢鱼体色较淡,因而又称白
鲢,在水域的上层活动,以
硅藻、绿藻等浮游植物为食。
鳃盖 胸鳍 尾鳍
臀鳍
腹鳍
鳙鱼头较大,故又名
“胖头鱼”,背面暗黑
色,并有不规则黑点,
因而俗称花鲢,栖息
在水的中上层,以水
蚤等浮游动物为食。
草鱼体色为青黄色,
栖息在水域的中下
层和水草多的岸边,
主要以水草为食。
青鱼体色为青黑色,栖息
在水域中下层,主要以螺、
蚌等软体动物为食。
20鲳鱼身体略呈菱形,头
小,背鳍和臀鳍较长,
海水鱼
尾鳍呈叉形。
鲨鱼处于海洋食物链的顶
端,鲨鱼中有体形最大的
鱼类鲸鲨,也有小到可以
放在手上的侏儒角鲨,还
有凶猛的大白鲨。
石斑鱼分布于热带、亚热带
暖水海域,头较大,体色与
四周岩石的颜色相似,有条
纹和斑点。石斑鱼幼体为雌
鱼,发育到一定阶段时,可
转变为雄鱼。
带鱼身体呈带状,口大,
背鳍较长,几乎与背部
等长。带鱼比较凶猛,
以鱼类、软体动物为食。
比目鱼栖息于海底,成鱼的
眼睛移到身体的同一侧,没
有眼睛的那侧身体朝向海
底。比目鱼的两只眼睛生在
一侧,是与它的生活环境和
21
生活方式相适应的。鱼的主要特征
鱼之所以能够在水中生活,有两个特点至关重
要:一是能靠游泳来获取食物和防御敌害;二是能
在水中呼吸。
取一条鲫鱼(或其他常见鱼),放在解剖盘中,观察鲫鱼的外部形
态。用手摸一摸鱼的体表,感觉一下鱼体表的特点。轻轻掀起鳃盖,看
一看鳃的形态和颜色,对照鳃的图片,想一想,鳃为什么是鲜红色的?
鳃丝为什么既多又细?
将鱼放在盛有清水的玻璃缸中,观察
鱼在水中是如何运动的。鱼在呼吸时,它
的口和鳃盖后缘是同时张合,还是交替张
合?用吸管吸取一些墨汁(或有颜色的果 鳃盖
汁、蔬菜汁),慢慢地滴在鱼口的前方,
观察墨汁流入鱼口后,会不会顺着鳃盖后 鳃丝
缘流出来?
鱼鳃
讨 论
!
❶ 鱼的外形有什么特点?是否有利于克
服在水中运动的阻力? 实验结束后,须将
❷ 有人说,鱼只靠鳍进行运动,这种说 鱼迅速放回清水中。
法全面吗?
❸ 水流入鱼口后,从什么地方流出?流
入的水和流出的水,溶解的气体成分会有哪些变化?
❹ 鱼鳃的哪些特点对它在水中呼吸是至关重要的?鱼离开水后,很快
就会死亡,原因是什么?
通过观察可以知道,鱼的身体分头部、躯干部
和尾部三部分,通常左右侧扁,大多呈流线型,这
样的体形有利于减少鱼在水中运动时遇到的阻力。
鱼的体表常常有鳞片覆盖,鳞片的表面有滑滑的黏
22 第五单元 生物圈中的其他生物液,起保护身体的作用。鱼的脊柱能支撑整个身
体,它的两侧附着有发达的肌肉,对运动起着重要
作用。鱼在水中通过尾部和躯干部的摆动以及鳍
(fin)的协调作用游泳。 ?
鱼是用鳃呼吸的,鳃的主要部分是鳃丝,鳃丝
在水中生活的其他种
中密布毛细血管。当鱼的口和鳃盖后缘交替张合时,
类的动物都是用鳃呼吸的
水从口流进,经过鳃丝时,溶解在水里的氧就渗入 吗?
鳃丝中的毛细血管;而血液里的二氧化碳就从毛细
血管渗出,排到水中,随水从鳃盖后缘排出体外。
由此可知,鱼的主要特征是:生活在水中;体
表常有鳞片覆盖;用鳃呼吸;通过尾部和躯干部的
摆动以及鳍的协调作用游泳。
鱼与人类生活的关系
鱼类养殖业和捕捞业都是国家的重要产业,
千百万人以渔业为生。鱼不仅为人类提供了富含蛋
白质的食物,还深深融入了人类的文化。年画中的
鱼寓意年年有余(图5-20)。“临渊羡鱼,不如退
而结网”“授之以鱼,不如授之以渔”等格言给人
以深刻的启示。“竭泽而渔”这个成语则告诫人们
不能只图眼前利益,不顾长远发展,对鱼类等生物
资源的利用也不例外。
然而,由于长期过度捕捞和水污染等原因,鱼
类的生存面临严重的威胁。为了合理利用和保
护鱼类资源,我国于1986年起施行《中华人民
共和国渔业法》。渔业法规定
“国家对渔业生产实行以养殖
为主”,经过数十年的努
力,我国渔业发展的重心
已经从捕捞业转移到养殖业
图5-20《 “莲”年有余》
杨柳青年画
第一章 动物的主要类群 23上。为了保护产卵期的亲鱼和肥育期的幼鱼,渔业
法还规定“禁止在禁渔区、禁渔期进行捕捞”“禁
止使用小于最小网目尺寸的网具进行捕捞”。
练习
1. 完成下面的图解。
鱼
体
形
特
点 呼
吸
运动方式
表 器
官
体
2. 有些动物如“章鱼”“带鱼”“墨鱼”“鱿鱼”,名称里都有“鱼”字,它们
都是鱼吗?
3. 在生长有较多藻类的池塘中,常常可以看到鱼在黎明时浮头甚至跳出水
面的现象,而在天亮以后(尤其在太阳出来一段时间后),鱼便停止了浮
头。联系前面学过的有关呼吸作用和光合作用的知识,思考一下,这是
什么道理?
4. 进入鱼体和流出鱼体的水中,溶解的气体成分有什么变化?请根据以下提
示设计实验进行证明。
提示:溴麝香草酚蓝简称BTB,遇二氧化碳后,BTB溶液的颜色会由蓝色
变成黄色。短时间内使用BTB对鱼没有影响。
饲养观赏鱼
你有饲养观赏鱼的经验吗?你知道养
鱼应注意哪些问题吗?如果你不太清楚的
话,建议你查找一下相关资料或向有关人
士咨询。动手饲养几条观赏鱼,欣赏它们
在水中的优美姿态吧!
24 第五单元 生物圈中的其他生物第五节 两栖动物和爬行动物
想一想,议一议
青蛙和龟既可以在水中游泳,
也可以在陆地生活,然而,青蛙
属于两栖动物,而龟却属于爬行
动物,这是为什么呢?
两栖动物
通过本节学习,你将知道:
你一定知道青蛙是由蝌蚪发育来的。蝌蚪无论 ◂ 两栖动物和爬行动物的
是外部形态还是内部结构都像鱼,有尾,用鳃呼 主要特征是什么?
吸,只能像鱼一样在水里生活。蝌蚪发育成青蛙以 ◂ 它们与人类的生活有什
么关系?
后,尾和鳃都消失了,生出四肢和肺,可以在陆地
上生活。青蛙属于两栖动物(amphibian)。
在野外观察时,你会在稻田、池塘、溪流边的
陆地上或水中发现青蛙。它如何适应这样的生活环
境呢?
鼻孔
观察青蛙(或牛蛙)的形态特征,
眼睛
若无实物,也可观察右边的图示。
鼓膜
讨 论 前肢
❶ 青蛙的身体表面是什么颜色的?这
与它的生活环境有什么关系?
❷ 当你把青蛙握在手中时,你有什么
感觉?
后肢
❸ 比较青蛙前肢和后肢形态上的差
别,想一想,这与前后肢的功能有
什么关系?
第一章 动物的主要类群 25通过观察你会发现,青蛙的眼睛后面有鼓膜,
可感知声波;头部前端有一对鼻孔,是呼吸时气体
毒腺 的通道;青蛙的前肢短小,可支撑身体;后肢发
达,趾间有蹼,既能跳跃也能划水。
青蛙身体的这些特点,使它既能在陆地上生
活,也能在水中活动。青蛙能适应陆地生活,还
与它能用肺呼吸密不可分。不过,青蛙的肺结构简
单,不发达。青蛙的皮肤裸露且能分泌黏液,湿润
的皮肤里密布毛细血管,也可进行气体交换,以辅
助肺呼吸。
图5-21 蟾蜍 蟾蜍、大鲵、蝾螈等与青蛙一样都是两栖动物
蟾蜍俗称癞蛤蟆,眼睛后方有
(图5-21,图5-22)。它们的主要特征是:幼体生
一对大型毒腺,所分泌的毒液
活在水中,用鳃呼吸;成体大多生活在陆地上,也
能制成中药蟾酥。
可在水中游泳,用肺呼吸,皮肤可辅助呼吸。
大鲵又叫娃娃鱼,现存最大的两 蝾螈终生有尾,生活在清冷的
栖动物,终生有尾,是国家二级 静水池沼里,有时也爬到陆地
保护动物。 上来。
图5-22 大鲵和蝾螈
两栖动物是很多农田害虫的天敌,保护稻田中
的青蛙或在稻田中放养青蛙,能有效减轻农作物的
虫害,以减少施用农药对环境的污染。目前,由于
环境污染以及水域面积缩减等原因,两栖动物的种
类和数量正在减少。我们应当加大保护两栖动物生
活环境的力度,同时禁止对它们乱捕滥杀。
26 第五单元 生物圈中的其他生物爬行动物
爬行动物(reptile)是真正适应陆地环境的脊
椎动物,身体结构和生活方式与两栖动物差别很
大。蜥蜴(图5-23)是十分常见的爬行动物。
蜥蜴一生都生活在陆地上。在温暖的日子里,
在田野和山坡的草地上,常常可以看到蜥蜴。蜥蜴
的头部后面有颈,因此它的头可以灵活地转动,便
图5-23 蜥蜴(草蜥)
于在陆地上寻找食物和发现敌害;蜥蜴的四肢短
小,不能跳跃,但能贴地面迅速爬行;皮肤干燥,
表面覆盖角质的鳞片(图5-24),既可以保护身体
又能减少体内水分的蒸发。
蜥蜴的肺比青蛙的发达,气体交换能力较强,
只靠肺的呼吸,就能满足蜥蜴在陆地上对氧气的
需求。
青蛙将卵产在水中并在水中受精,而蜥蜴将受
图5-24 蜥蜴的皮肤表面覆盖
精卵产在陆地上。蜥蜴的受精卵较大,卵内养料较
角质的鳞片(麻蜥)
多并含有一定的水分,卵外还有坚韧的卵壳保护,
使卵能够在陆地环境中发育成幼蜥。因此,蜥蜴的
生殖和发育可以摆脱对水环境的依赖,这也是蜥蜴 图5-25 扬子鳄
扬子鳄是小型鳄类,我国特有
能终生生活在陆地上的重要原因。
的一级保护动物。主要分布在
同属于爬行动物的龟、鳖、蛇、鳄(图5-25)
安徽、江苏、浙江三省长江沿
等动物,外形和蜥蜴有较大差别,但是,它们都具 岸的局部地区。生活在水边
的芦苇丛中或竹林地带,以田
有以下主要特征:体表覆盖角质的鳞片或甲;用肺
螺、鱼、蛙等为食。现已人工
呼吸;在陆地上产卵,卵表面有坚韧的卵壳。
繁育成功。
27爬行动物与人类生活有着密切的关系。请仔细
阅读下面的图文资料(图5-26),想一想你还能作
出哪些补充。
鳖
人工养殖的鳖可以食用,鳖甲
可以入药。
蝮蛇 眼镜蛇
我国约有50种毒蛇,常见的有蝮蛇、眼镜蛇、银环
蛇、竹叶青等。毒蛇能伤人,但蛇毒也能治病。
避役
避役俗称变色龙,能捕食昆虫,
其中包括危害林木的昆虫。
图5-26 爬行动物与人类生活
的关系示例 你可能早就听说过恐龙和爬行动物时代。科学
研究表明,在距今2亿年前,地球上的爬行动物非
常繁盛,它们占据着那时的陆地、海洋和天空。在
随后的一亿多年间,爬行动物都占有绝对优势,因
而人们称那个时代为爬行动物时代。后来,这些爬
行动物大多数都灭绝了。人们对灭绝的原因有不同
的推测,你可以搜集相关资料,进一步了解。
28 第五单元 生物圈中的其他生物翼龙
马门溪龙 霸王龙
剑龙
鱼龙
几种古爬行动物的复原图
练习
1. 判断下列说法是否正确。正确的画“√”,错误的画“×”。
(1)既能在水中生活,又能在陆地上生活的动物,属于两栖动物。 ( )
(2)有的两栖动物终生生活在水中。 ( )
(3)两栖动物的生殖和发育离不开水,爬行动物的生殖和发育摆脱了对水环境
的依赖。 ( )
2. 请将下列与青蛙、蜥蜴有关的叙述分别用线连起来。
体表覆盖鳞片
青蛙 皮肤湿润,可辅助呼吸
产的卵具有坚韧的卵壳
蜥蜴 幼体生活在水中,成体大多生活在陆地上
终生生活在陆地上
3. 鱼的鳃、青蛙的肺和皮肤、蜥蜴的肺都能与外界进行气体交换,它们在结
构上有什么共同的特点?
4. 蛇没有四肢,但它属于爬行动物。这是为什么?
5.“ 稻花香里说丰年,听取蛙声一片。”这句话对青蛙及其与农业生产的关系
作了生动的描述。为什么现在许多稻田里听不到蛙声了呢?
第一章 动物的主要类群 29第六节 鸟
想一想,议一议
有些鸟能在南、北半球之间迁飞往返,
有些鸟竟能飞越珠穆朗玛峰!它们为什么具
有这么强的飞行能力呢?也许你会回答:因
为鸟有翅膀。那么,人在双臂上缚上人工翅
膀,为什么还是不能像鸟一样飞呢?
多种多样的鸟
通过本节学习,你将知道:
◂ 鸟的主要特征是什么? 说到鸟(bird),你一定不陌生吧!天上飞的,
◂ 鸟与人类的生活有什么 地上走的,水里游的,在很多地方都能见到鸟的踪
关系? 迹。鸟的种类很多,是脊椎动物中种类数量仅次于
鱼的一个类群。
观察下面的几种鸟(标本或图片),比较它们在形态结构上的异同。
大山雀 丹顶鹤
金雕 啄木鸟
野鸭
30 第五单元 生物圈中的其他生物讨 论
❶ 试着完成下面的表格。
鸟的名称 喙的特征 足的特征 食性 生活环境
大山雀 短、直 纤细,善于抓握 以食虫为主 林间
金雕
丹顶鹤
啄木鸟
野鸭
❷ 根据上面的表格,试推测鸟喙的特征与鸟的食性之间有什么联系,
鸟足的特征与鸟的生活环境有什么联系。
❸ 这些鸟在外部形态上有什么共同特点?
鸟的主要特征
天高任鸟飞。除了鸵鸟、企鹅等少数鸟不能飞
行以外,绝大多数鸟都是善于飞行的。它们的形态
结构是如何与飞行生活相适应的?下面的探究将有
助于解答这一疑问。
鸟适于飞行的形态结构特点
问 题
鸟的形态结构有哪些适于飞行的特点?
作出假设
你的假设是 。
制订并实施计划
你打算选择哪种鸟进行观察?你将观察哪些项目以检验你的假设?
当你进行观察时,以下提示也许对你有帮助。
如果你所提出的假设无法全部通过观察来检验,请你在老师的指导
下查找相关资料。
第一章 动物的主要类群 31鸟的外形
鸟的翼和羽毛
胸骨
胸肌
鸟的胸肌 鸟的骨骼
提 示
● 家鸽、麻雀或其他善飞的鸟(活体或标本),都可以作为观察对象。
● 你所观察的鸟的体形是怎样的?这与它的飞行生活有什么关系?
● 将鸟的翅膀轻轻展开,你将发现排列整齐的较大型的羽毛,这些羽
毛既有彼此重叠的部分,又相互留有空隙,想一想,这与飞行有什
么关系呢?
● 摸摸鸟的胸肌,与其他部位的肌肉相比,胸肌的发达程度怎样?
● 看看鸟的骨骼,可以发现胸部的骨很突出。将胸骨的特点与这块骨
上附着的肌肉联系起来考虑,你会作出怎样的推测?
得出结论
你得出的结论是 。
表达和交流
将你的探究结果与同学交流。你们得出的结论一致吗?交流过程对
你完善自己的结论有帮助吗?
32 第五单元 生物圈中的其他生物通过探究我们知道,鸟有许多适于飞行的特点。
身体呈流线型,可减少飞行中空气的阻力。体表覆
羽(feather),前肢变成翼(wing),翼上生有几排大
型的羽毛。翼搏击空气,使鸟能振翅高飞,或平稳
滑翔。骨骼轻、薄、坚固,有些骨内部中空,可减
轻体重。胸骨上高耸的突起叫作龙骨突;胸肌发达,
附着在胸骨上,牵动两翼完成飞行动作。
鸟的视觉发达,有些能在疾飞中捕食。用坚
硬的角质喙(bill)来啄取食物,没有牙齿(图
图5-27 鸟有喙无齿(黄嘴鸢)
5-27)。食量大,消化能力强,食物经消化吸收后
形成的残渣很快就随粪便排出。
鸟的呼吸作用旺盛,具有与肺相通的气囊(图
5-28),可辅助呼吸。心跳频率快,体温高而恒
定。鸟的体温不会随着环境温度的变化而改变,是
恒温动物(homeotherm)。鱼、两栖动物和爬行
动物,体温随环境温度的变化而改变,是变温动物
(poikilotherm)。恒定的体温增强了动物对环境的
适应能力,扩大了动物的分布范围。
与爬行动物一样,鸟也通过产卵繁殖后代,卵
表面有坚硬的卵壳,起保护作用。
鸟的主要特征是:体表覆羽;前肢变成翼;有
喙无齿;有气囊辅助肺呼吸。
气管
图5-28 鸟体内的气囊
气囊与肺相通,主要分布在内脏器官之间。吸气
时,吸进的空气一部分在肺内进行气体交换,一 肺
部分则直接进入气囊;呼气时,气囊内的气体
又返回肺内进行气体交换。这样,鸟不论吸
气还是呼气,肺内都有富含氧气的空 气囊
气通过,从而提高了气体交
换的效率。
第一章 动物的主要类群 33鸟与人类生活的关系
下图列举了鸟与人类生活关系密切的几个事例
(图5-29)。除此之外,你还能作补充吗?
猫头鹰等猛禽是鼠类的天敌,大 鸡、鸭、鹅等家禽是人类食物 鸟具有很高的观赏价值,观鸟
山雀、啄木鸟等捕食农林害虫。 中动物蛋白的重要来源。 增进了人与鸟之间的情感。
图5-29 鸟与人类生活的关系示例
鸟是生物圈的重要成员,是维持生态系统稳定
的重要因素,是人类生存和发展的重要伙伴。爱鸟
护鸟,人人有责!
练习
1. 判断下列说法是否正确。正确的画“√”,错误的画“×”。
(1)前肢变为翼是鸟适于飞行的唯一特征。 ( )
(2)爬行动物和鸟的生殖发育完全摆脱了对水环境的依赖,是真正的陆生
脊椎动物。 ( )
2. 下面哪一组是鸟特有的特征?( )
①体表有羽毛 ②用肺呼吸并用气囊辅助呼吸 ③体温恒定
④通过产卵繁殖后代 ⑤前肢覆羽成翼 ⑥善于飞行
A.①③⑥; B.②③④; C.①②⑤; D.②⑤⑥。
3. 如果你注意观察家鸽或麻雀,会发现它们总在不停地找食吃。它们吃进去
这么多东西,难道不会增加体重、影响飞行吗?
4. 有人说,鸟的全身都为飞行而设计。请谈谈你对这句话的理解。
34 第五单元 生物圈中的其他生物动物与造型艺术
绘画和雕塑都是造型艺术。动物那生动的
姿态和神韵不仅带给人美的享受,而且给人以
遐思和启迪,因而成为绘画和雕塑中的常客。
天安门前的石狮,庄严威武;华表上的盘
龙,壮志凌云;深圳的“拓荒牛”则展现了拓 毕加索的“和平鸽”
荒者埋头苦干的精神和坚忍不拔的意志。
毕加索的“和平鸽”使人体会到和平得来
的不易;而北京街头的雕塑“少女与和平鸽”
则让人悟到和平的圣洁和温馨。
徐悲鸿“马”的奔放、齐白石“虾”的活
泼、李苦禅“鹰”的冷傲、李可染“牧童与牛”
的闲适,都给人以美的享受。
动物给造型艺术增添了活力,造型艺术中
的“动物”则可以净化心灵,引人向上。让我
以动物为原型设计的玩具
们关爱并保护人类的朋友——动物,这可以使我
们的生活更美好。
深圳的“拓荒牛”
第一章 动物的主要类群 35第七节 哺乳动物
想一想,议一议
右图争相吃奶的小狗多可爱!哺乳动物
用乳汁哺育幼仔。小动物一般在出生后,就
会吮吸乳汁。与其他抚育后代的方式相比,
哺乳有什么优越性?
草原上纵情驰骋的野马,原野上怡然漫步的非
通过本节学习,你将知道:
◂ 哺乳动物的主要特征是 洲象,森林里攀援自如的猕猴,海洋中一跃激起千
什么? 重浪的鲸,挖洞的鼹鼠,飞翔的蝙蝠……这些都是
◂ 哺乳动物与人类的生活 哺乳动物(mammal)(图5-30)。它们形态各异,
有什么关系?
生活环境差别很大,为什么都属于哺乳动物呢?
哺乳动物的主要特征
除了鲸等少数水生种类的体毛退化以外,哺乳
动物的体表都被毛(hair)。体毛有很好的保温作
用。与鸟一样,哺乳动物可以维持恒定的体温,是
恒温动物。
哺乳动物的生殖方式与其他动物不同:绝大多
数哺乳动物的胚胎在雌性体内发育,通过胎盘从母
? 体获得营养,发育到一定阶段后从母体中产出,这
种生殖方式叫作胎生。雌性用自己的乳汁哺育后
为什么胎生、哺乳
代,使后代在优越的营养条件下成长。胎生、哺乳
提高了哺乳动物后代的
成活率? 提高了后代的成活率。
与鸟用喙啄取食物不同的是,哺乳动物用牙齿
(tooth)撕咬、切断和咀嚼食物。它们的牙齿有什
么特点呢?
36 第五单元 生物圈中的其他生物图5-30 多种多样的哺乳动物
猕猴在森林里群居生活,栖息在树上,以
野果为食,也吃鸟卵和昆虫。
野马栖息于草原、荒漠,原分布于我国新疆北部等
地。野生的野马已经灭绝,我国于20世纪80年代 非洲象是陆地上最大的哺乳动
从欧美重新引入野马,经饲养后放归野外。 物,栖息于森林和稀树草原,
主要吃香蕉等果实以及树叶、
树皮。
鲸是生活在海洋中的大型哺乳
动物,有些鲸浮出水面时像一
座小岛,食物是水母、乌贼、
虾和一些不大的鱼,食量很
大。图中所示为白鲸。
37观察右图,比较兔、狼的牙齿。
门齿 门齿 臼齿
讨 论
❶ 兔和狼的牙齿有什么共同特点? 犬齿
❷ 兔和狼的牙齿有什么不同?这
与它们的生活习性有什么关系?
臼齿
❸ 牙齿的分化对摄食和消化有什
兔的牙齿 狼的牙齿
么意义?
通过上面的活动可以发现,哺乳动物的牙齿有
小资料
门齿、犬齿和臼齿的分化。牙齿分化既提高了哺乳
为保护和拯救珍
稀、濒危野生动物, 动物摄取食物的能力,又增强了对食物的消化能力。
保护、发展和合理利 另外,哺乳动物还具有高度发达的神经系统和
用野生动物资源,我
感觉器官,能够灵敏地感知外界环境的变化,对环
国制定和实施了《中
境的复杂多变及时作出反应。
华人民共和国野生动
物保护法》。 哺乳动物的主要特征是:体表被毛;胎生,哺
乳;牙齿有门齿、犬齿和臼齿的分化。
图5-31 导盲犬 哺乳动物与人类生活的关系
哺乳动物与人类的生活息息相关。想一想,哺
乳动物有哪些重要用途?
家畜是由野生动物驯养而来的,是人类食物中
动物蛋白的重要来源。有些人为获取皮毛或贪吃“野
味”而捕猎野生哺乳动物。疯狂的捕猎已导致野生
动物种类数量锐减,也屡屡导致“潜伏”在野生动
物身上的病原体(致病的病毒、细菌等)传染给人类,
引发传染病。因此,滥食野生动物的陋习应当彻底
革除。
哺乳动物的用途还有很多。例如,导盲犬、警
犬、军马等是人类得力的助手(图5-31)。
38?
人类的生活有时候也会受到哺乳动物的困扰。
为什么国家禁止施用
例如,鼠类猖獗会对农、林、牧业造成危害,有时
“毒鼠强”等剧毒鼠药灭
还会传播疾病。对这些动物进行合理防控是必要 鼠?你认为是否应该将鼠
类彻底消灭?
的,但是,怎样才能做到合理防控,仍然是需要探
索的课题。
综合和概括
动物的种类如此之多,它们有没有什么共同的特征呢?综合前面学
过的内容,看看下面的概括是否全面、准确。
动物不能像植物那样自己制造有机物,必须靠吃现成的有机物生
活。有的动物以植物为食,有的动物以其他动物为食,有的动物既吃植
物又吃其他动物。
动物要维持生存,既要善于发现和获取食物,又要避免被其他动物
捕食。发现食物或敌害要靠神经系统(包括感觉器官),获取食物或防
御敌害离不开运动。绝大多数动物都能自由运动。
对以上概括,你有什么修改或补充吗?
练习
1. 下列动物中,不属于恒温动物的是:( )
A.猎豹; B.响尾蛇; C.企鹅; D.大猩猩。
2. 下列关于胎生、哺乳的叙述,不正确的是:( )
A.绝大多数哺乳动物以胎生的方式繁殖后代;
B.哺乳为幼仔成长提供优越的营养条件;
C.胎生、哺乳大大降低了幼仔的死亡率;
D.胎生提高了哺乳动物的产仔率。
3.“ 鲸”,人们俗称“鲸鱼”。为什么说“鲸”是哺乳动物,而不是鱼?
4. 我国洞庭湖区曾爆发过一场触目惊心的“人鼠大战”。想一想,鼠害成灾的
原因有哪些?人类应该怎样将有害动物的数量控制在合理水平?
第一章 动物的主要类群 39兽医师
也许你在电视、报纸上见过这样的报道,某
地禽流感疫情爆发,禽类染病后大批死亡。引
起禽流感的病毒中有些是高致病性的,有的
还会从禽类传染给人,致使人患病甚至死亡,
对社会造成严重的影响。近些年来,我国采
取了一系列的防控措施,使禽流感疫情得到
了有效的控制,其中就有兽医师的一份功劳。
现在,很多人搞起了养殖,有的办起了养殖
场,还有的开起了养殖公司。饲养动物可不是一件
轻松的事情。动物在养殖过程中可能会出现各种各样的状况,如食欲不
振、腹泻、突然死亡等等。遇到这些情况,养殖户往往不知道该如何处
理,这就需要兽医师给予技术指导,对动物及时诊治。为了预防一些重
大动物疫病如禽流感、口蹄疫、猪瘟,还需对动物进行免疫注射,以增
强动物对疾病的抵抗力。养殖的动物在进入市场交易之前,通常须对动
物进行严格的检疫,以保证市场上肉类食品的安全。这些工作的开展,
都离不开兽医师。
总的来说,兽医师的工作主要是对动物疫病进行防治。如果你养过
猫、狗等动物,你可能带它们去过宠物医院或动物医院,那里的兽医师
会为动物检查身体、治疗疾病。如果动物伤得比较严重,兽医师还要对
动物实施外科手术。
你现在对兽医师这个职业有所了解了吧。兽医师的工作可不简单,
没有一定的专业知识和技能是无法胜任的。就像医生需要通过执业医师
资格考试一样,要想成为一名合格的兽医师,须参加全国执业兽医资格
考试,取得执业资格才行。
40 第五单元 生物圈中的其他生物第二章
动物的运动和行为
从电视上你可能见过这样的镜头:在非洲草原
上,几头狮子正在悄悄地潜近斑马群,斑马似乎感
觉到什么,突然停止了取食,昂头屏息,凝神谛
听,一发现敌害便迅速奔逃(图5-32)。你也许还
看到过孔雀开屏、大雁迁徙、蜜蜂采蜜,等等。动
物所进行的这一系列有利于它们生存和繁殖后代的
活动,都是动物的行为(animal behavior)。
图5-32 斑马的防御行为
动物的行为常常表现为各种各样的运动。动物
斑马感觉到了狮子的威胁,迅
的运动依赖于一定的身体结构。 速奔跑。
41第一节 动物的运动
想一想,议一议
动物一般都能自由运动,它们的运
动方式多种多样,运动速度有很大差别。
想一想,昆虫、鱼、鸟和哺乳动物的运动器官
有什么不同?有人说,动物的运动本质上都依
靠肌肉的收缩。你同意这种说法吗?
通过本节学习,你将知道: 你已经了解了许多动物的运动方式,如蚯蚓的
◂ 运动系统是由哪些部分 蠕动,鱼的游泳,鸟的飞行,哺乳动物的行走、奔
组成的? 跑、跳跃等。动物的运动器官是怎样完成各种动作
◂ 骨、关节和肌肉怎样协调
的呢?让我们以哺乳动物为例来探究,当然,你也
配合完成动作?
可以把自己当作探究的对象。
◂ 运动对于动物的生存具
有什么意义?
运动系统的组成
请你做一做屈肘和伸肘的动作,想一想,这个
动作是靠哪些结构完成的?如果肘关节受伤了,还
能正常完成这些动作吗?为什么发生骨折或肌肉拉
伤,相应的部位不能正常运动?
分析下列资料。
❶ 观察哺乳动物(如家兔)
的骨骼标本,特别是它的
股骨
前肢和后肢,注意它们分 肱骨
腓骨
别是由哪些骨组成的,并 桡骨 胫骨
尺骨
试着在自己的上肢和下肢 腕骨
掌骨
找一找相应的骨。 指骨 趾骨跖骨跗骨
家兔的骨骼
42 第五单元 生物圈中的其他生物!
使用剪刀或解剖刀等
关节头 工具时,要注意安全。
关节囊
肌腹
关节腔 肌腱
关节窝
关节软骨
关节示意图 已除去部分皮肤的鸡翅
关节周围由关节囊包裹着,内部形成密 肌肉中间较粗的部分叫肌腹,两端较细的呈
闭的关节腔。关节腔内含有滑液,可以 乳白色的部分叫肌腱,肌腱可绕过关节连在
减少骨与骨之间的摩擦。 不同的骨上。
❷ 利用剖开的哺乳动物(如家兔、羊)的关节,对照关节示意图,观
察关节的结构。注意关节是由哪几部分组成的,想一想,关节在运
动中起什么作用?
❸ 取一个完整的鸡翅(已除去羽毛),用解剖剪除去皮肤,观察肌肉
是怎样附着在骨上的。依次拉动每一组肌肉,观察骨的运动。然后,
除去肌肉,观察骨与骨之间的连接。
讨 论
❶ 骨、关节和肌肉在结构上有什么关系?三者如何配合产生运动?
❷ 关节对骨的运动有什么意义?如果用房间的门来打比方,它相当于
门上的什么结构?
❸ 蚯蚓体内有肌肉,但是没有骨骼,这是它不能快速运动的原因吗?
❹ 举例说出人体哪些部位有关节。进行体育运动时,哪些关节容易受
伤?应当怎样保护?
通过上面的活动可以知道,运动系统主要是由
骨(bone)、关节(joint)和肌肉(muscle)组成
的。骨与骨之间通过关节等方式相连形成骨骼,附
着在骨骼上的肌肉称为骨骼肌(skeletal muscle)。
第二章 动物的运动和行为 43骨、关节和肌肉的协调配合
小资料
骨的位置变化产生运动,但是骨本身是不能运
人体的骨骼由
动的。骨的运动要靠骨骼肌的牵拉。骨骼肌受神经
206块骨连接而成,约
占体重的20%。骨与 传来的刺激收缩时,就会牵动骨绕关节活动,于是
骨之间的连接方式主 躯体的相应部位就会产生运动。但一组骨骼肌只能
要有三种:头部颅骨
收缩牵拉骨改变位置,而不能将骨复位,骨的复位
的各骨之间多以骨缝
要靠另一组骨骼肌的收缩牵拉,可见与骨连接的肌
相连,不能活动;脊
肉中,至少有两组相互配合完成运动。例如,当肱
椎骨之间以椎间盘相
连,活动范围小;其 二头肌收缩,肱三头肌舒张时,肘部弯曲;肱三头
他骨之间多以关节相
肌收缩,肱二头肌舒张时,肘部伸展(图5-33)。
连。人体内的骨骼肌
你不妨再做一次肘部屈伸的动作,体会一下屈肘和
有600多块,约占体
重的40%。 伸肘时,分别是哪块肌肉在用力?为了更明显地体
会到伸肘时也需要肌肉收缩,可以把胳膊高高举
起,再做屈伸动作。
其他哺乳动物的运动也是这样产生的。当然,
运动并不是仅靠运动系统来完成的,还需要其他系
统如神经系统的调节。运动所需的能量,有赖于消
化系统、呼吸系统、循环系统等系统的配合。
肱二头肌收缩
肱二头肌舒张
肱三头肌收缩
肱三头肌舒张
图5-33 屈肘动作(左)和伸肘动作(右)
44 第五单元 生物圈中的其他生物哺乳动物主要靠四肢支撑起身体,骨在骨骼肌
试一试
的牵拉下围绕着关节运动,从而使躯体能够完成各
用2~3块硬纸
种动作,具有很强的运动能力。强大的运动能力,
板(代表骨)、适当
有利于动物寻觅食物、躲避敌害、争夺栖息地和繁
长度的松紧带(代表
殖后代,以适应复杂多变的环境。 肌肉)和几个工字钉
(代表关节),制作一
哺乳动物之外的其他的动物,它们的运动方式
个用来演示肌肉牵动
和运动能力千差万别。例如,水螅主要固着在水草
骨运动的模型。
等物体上,很少移动身体;蜗牛依靠肉质足缓慢爬
行;蚯蚓只有肌肉没有骨骼,也只能缓慢地蠕动;
蝗虫有肌肉和外骨骼,胸部具有三对足和两对翅,
既能够跳跃,也善于飞行;家鸽与飞行有关的肌肉
非常发达,还具有轻而坚固的骨骼,飞行速度快,
飞行距离远。
练习
1. 判断下列说法是否正确。正确的画“√”,错误的画“×”。
(1)哺乳动物的运动系统由骨和肌肉组成。 ( )
(2)只要运动系统完好,动物就能正常运动。 ( )
2. 下列表示骨、关节和肌肉的模式图中,正确的是:( )
① ②
3. 当你做任何一个动作时,都会包括以下步骤:①相应的骨受到牵引,②骨
绕关节转动,③骨骼肌接受神经传来的兴奋,④骨骼肌收缩。这些步骤发
生的正确顺序是:( )
A. ①②③④; B. ②①③④; C. ③④①②; D. ④①②③。
4. 根据本节所学哺乳动物的运动的内容,推测鸟的胸肌的两端是否都附着在
胸骨上?为什么?
5. 请你用一句话概括骨、关节、肌肉在运动中的作用,并与同学交流,看谁
的概括更准确、更精练。
第二章 动物的运动和行为 45借动物以言志
当你在自然界畅游时,大自然中的鸟语花香、飞禽走兽会给你带来
无穷的乐趣与遐想。古往今来,中外作家和诗人借动物以言志,留下许
多名篇佳作。
我国现代著名作家杨朔的散文《荔枝蜜》,通过对蜜蜂采蜜的生动
描写,来赞美广大劳动人民辛勤劳动、无私奉献的精神。
苏联作家高尔基的散文《海燕》,刻画了海燕在暴风雨中勇敢飞翔
的大无畏精神,给人以巨大的鼓舞和激励。
英国著名诗人雪莱的《云雀歌》,以高飞入云的欢歌的云雀,来
抒发高远的志向和对美好未来的追求:“你好!欢乐的精灵!你何尝
是鸟!从悠悠的天庭,倾吐你的怀抱。你不费思索,而吟唱出歌声曼
妙……你嘹亮的歌喉,响彻普天之下,像一朵孤云后边,月儿把清辉流
洒,幽暗的夜空于是荡漾着万顷光华。”
毛泽东同志的“鹰击长空,鱼翔浅底,万类霜天竞自由!怅寥廓,
问苍茫大地,谁主沉浮?”抒发了以天下为己任的豪情壮志。
动物不仅在科学和技术上给人以启迪,同时也是人类文学创作的源
泉。认真观察动物,仔细领略其奥秘,会使人获益匪浅。
46 第五单元 生物圈中的其他生物第二节 先天性行为和学习行为
想一想,议一议
你听说过吗?有
的乌鸦会从高处把坚
果(果皮硬的果实)
扔到水泥地面上摔
碎,从而轻松地吃到
里面的果仁。有些坚
果特别硬,不容易摔碎,乌鸦会用更好的方法:它衔住坚果驻足在红绿
灯杆上 , 等汽车来时扔下坚果,让汽车将坚果碾碎,为了安全起见,它
不会立刻飞下去吃果仁,而是等红灯亮时 , 再飞落地面去享受美味。
乌鸦这种行为是生来就有的吗?如果不是,这种行为又是怎样形成
的呢?
如果你养过猫、狗等宠物,一定会有这样的体
通过本节学习,你将知道:
会:它们不用你教,就会吃东西、睡觉,但是要想 ◂ 如何区分先天性行为和
让它们学会到规定地方去大小便,那可就费劲了。 学习行为?
◂ 动物的行为对动物的生
你知道这是为什么吗?
存有什么意义?
区分先天性行为和学习行为
动物的行为多种多样,如取食行为、防御行
为、攻击行为、繁殖行为、迁徙行为、领域行为、
社会行为等。
从行为获得的途径来看,动物的行为大致可以
分为两类。一类是动物生来就有的,由动物体内的
遗传物质所决定的行为,称为先天性行为(innate
behavior)。另一类是在遗传因素的基础上,通过环
境因素的作用,由生活经验和学习而获得的行为,
称为学习行为(learned behavior)。先天性行为是学
习行为的基础。
第二章 动物的运动和行为 47分析下列图片和文字资料。
蚯蚓走迷宫的实验 母袋鼠与幼袋鼠
❶ 在迷宫的一臂安上电极,而另 ❷ 刚出生的小袋鼠只有人的手指
一臂是潮湿的暗室,其中还有 那样大小,眼睛还睁不开。它
食物。当蚯蚓爬到安有电极的 出生时掉在母袋鼠的尾巴根
一臂时,它就会受到电击。经 部,靠本能爬到母袋鼠腹部的
过多次尝试和错误后,蚯蚓能 育儿袋中吃奶。
够学会直接爬向潮湿的暗室。
小鸟喂鱼 大山雀喝牛奶
❸ 一只红雀飞到池塘边,把衔来 ❹ 很多年前,在英格兰有一只大
的昆虫喂到鲤鱼张开的嘴里, 山雀,一次偶然机会碰巧打开
一天中来回了好几趟。它很可 了放在门外的奶瓶盖,偷喝了
能最近刚失去自己的雏鸟。 牛奶。不久,那里的其他大山
雀也学会了偷喝牛奶。
48 第五单元 生物圈中的其他生物菜粉蝶
黑猩猩钓取白蚁
菜粉蝶的幼虫——菜青虫
❺ 菜青虫总是取食白菜、甘蓝等 ❻ 幼小的黑猩猩能模仿成年黑猩
十字花科植物(十字花科植物 猩,用一根蘸有水的树枝从蚁穴
的花由四片花瓣组成,呈十字 钓取白蚁作为食物。成年黑猩猩
形排列)。有人用刚从受精卵 会利用经验来解决问题。有人通
里孵化出的菜青虫做实验:把 过实验发现了这样的现象:当香
十字花科植物的叶片榨成汁涂 蕉被挂在高处够不到时,黑猩猩
抹在滤纸上,旁边放着其他植 就会把几个木箱堆叠起来,然后
物的叶子,结果菜青虫去啃食 爬到木箱顶上去摘香蕉。
滤纸,却不吃其他植物的叶子。
讨 论
❶ 上述资料里描述的各种动物行为中,哪些是先天性行为?哪些是学
习行为?
❷ 对比分析资料1和资料2,先天性行为和学习行为对动物维持生存的
意义有什么不同?
❸ 分析资料3,试说说先天性行为有没有局限性。
❹ 不同动物的学习能力有差别吗?
第二章 动物的运动和行为 49动物的先天性行为使动物能适应环境,得以生
存和繁殖后代。动物的学习行为可以让它们更好地
适应复杂环境的变化。一般来说,动物越高等,学
习能力越强,学习行为越复杂。
研究一种动物的行为
研究动物行为的方法,主要有观察法和实验
法,以及这两种方法的结合。你可以选择身边熟悉
的一种小动物,先观察它具有哪些行为,再分析这
些行为哪些是先天性的,哪些是经过学习获得的,
必要时还可以设计实验进一步研究。下面提供一
个探究动物行为的方案,你可以参考,也可以选择
自己感兴趣的动物(如家里养的宠物、家禽、家畜
等),另定探究的课题和计划。
小鼠走迷宫获取食物的学习行为
如果你能找到小鼠、豚鼠或仓鼠做实验动物就太
好了,因为这类小动物经过训练,能在很短的时间内形
成一种新的行为。它们通常白天躲在黑暗处睡觉,夜晚才
仓鼠
出来活动,所以,选择它们做实验动物,你可要把握好做实验的
时间了。
“尝试与错误(trial and error)”是常见的学习行为。在前面介绍的
蚯蚓走“T”形迷宫的实验中,蚯蚓要经过大约200次尝试,遭受多次轻
微的电击后才能学会直接爬向潮湿的暗室。小鼠属于哺乳动物,学习能
力比蚯蚓强,“尝试与错误”的次数要少些。当然,也不排除不经“尝
试与错误”就能吃到食物的可能性。
提出问题
对小鼠走迷宫获取食物的行为,提出你要探究的问题。
你提出的问题是 。
50 第五单元 生物圈中的其他生物作出假设
你作出的假设是 。
制订计划
你所制订的计划中应当包括:确定作为研究对象的动物,制作“迷
宫”,准备适当的食物,选好实验场所和时间,确定实验记录的方法等。
下图的“迷宫”仅作为示例供你参考。
注意:“迷宫”的
隔板应高些,以避免
小鼠从隔板上方越过,
或者在隔板上方盖一
块玻璃板,这样既能阻
止小鼠翻越隔板又便于
观察小鼠的行为;“迷
宫”通道的宽度要便于
小鼠折返;实验前使小
鼠处于饥饿状态。
实施计划 “迷宫”示例
按你确定的计划进行探究。认真统计小鼠需要经过几次“尝试与错
误”才能通过“迷宫”,吃到食物。
分析结果,得出结论
实验结果支持你的假设吗?你的结论是
。
讨 论
❶ 跟同学交流这项探究的过程、结果和结论。如果用不同小鼠分别做实
验,它们“尝试与错误”的次数一样吗?如果不一样,说明了什么?
❷ 这项探究活动,还有哪些地方需要做进一步的改进?
❸ 你对家养的小动物进行过学习行为的训练吗?它们有哪些行为是学
习行为?这些行为对它们的生存有什么意义?
❹ 这项探究活动对你自己的学习有什么启发?
第二章 动物的运动和行为 51练习
1. 判断下列说法是否正确。正确的画“√”,错误的画“×”。
(1)先天性行为和学习行为是两种截然不同、互不相关的行为类型。
( )
(2)动物的学习行为一旦形成,就不会改变。 ( )
(3)动物的学习行为越复杂,适应环境的能力越强。 ( )
2. 刚出生的婴儿就会吃奶,这属于哪一类行为?这对他(她)的生存有什么
意义?
3. 从树丛到草间,从屋檐到墙角,常能找到形形色色的蛛网。这是蜘蛛的住
所、通讯线路、交通要道、捕食陷阱、“餐厅”、“婚房”和育幼室。有人观
察到,一只幼蛛从出生之日起就会自行结网,结网技巧与成年蜘蛛相比毫
不逊色。蜘蛛结网是先天性行为还是学习行为?
4. 动物越高等,学习行为越多吗?你能举一些例子吗?
动物行为学家的新装备
大雁迁飞万里,大熊猫、东北虎藏匿于
山林,对它们的行为进行研究,需要借助一
些装备才能完成。以前动物行为学家在进行
研究时,往往只能借助一些简单的装备,通
过艰苦的工作获得信息。随着科学技术的不
断发展,一些新装备的使用,让行为学家们
如虎添翼。
在野外,科学家首先需要准确地确定自 激光测距仪
己身处何处,这时,全球卫星定位系统就可
以派上用场了。该系统通过围绕地球分布的多颗卫星进行定位,可以确
定用户所处地点的经度、纬度、海拔等信息。在野外观察到动物时,要
精确判断它离自己有多远,可以用专业的测距仪。专业的测距仪大小跟
一般的望远镜差不多,同时具有望远镜的放大功能。它对1 500米以内
52 第五单元 生物圈中的其他生物的大型动物(如熊、天鹅)测距误差小于1米。
有些动物只在夜间活动,用夜视仪就可以在黑暗中有效地进行观
察。很多动物对人非常警惕,会远远地避开人;有些动物非常凶猛危
险,比如熊、雪豹、虎等。要追踪它们,就要用到红外自动照相机了。
在这些动物可能出现的地方布设红外自动照相机,动物经过的时候,它
们身体发出的红外线可触发相机自动启动并拍照。只要定期检查拍下的
照片,就可以了解某种动物是否出现过,出现过多少次。
在研究一个动物的活动范围时,以前主要是通过观察它的活动情
况,甚至只是活动的痕迹来确定范围大小,因此对一些生活在隐秘环境
中或人类不易接近的动物,难度会很大。如果捕捉动物后给它戴一个项
链或项圈一样的无线电发射器,再通过接收机接收无线电发射器发射的
信号,就可以确定动物的位置并追踪它。如果所研究的动物活动范围很
大,比如鸟类的迁徙,就要借助于卫星追踪设备了——给迁徙的鸟戴上
卫星发射器,卫星发射器定期发射信号,卫星接受信号后将信号传送给
地面的接收站,通过接收、处理卫星信号就可以确定鸟的活动位点。
除上述装备以外,动物行为学家还会用到不少其他的研究装备。随
着科学技术的进步,他们的装备还会越来越精良,对动物行为的研究会
越来越深入。
卫星发射器
无线电发射器
第二章 动物的运动和行为 53第三节 社会行为
想一想,议一议
火蚁是一种营群体生活的蚂蚁。在洪水来
临时火蚁会有这样的行为:一些工蚁彼此将前
后足搭接在一起,在水面上形成一个由身体搭
建的“筏子”;另一些工蚁则忙着把蚁后、雄
蚁和幼蚁搬到“筏子”上,最后,在水面上形
成一个漂动的“蚁团”。蚁团随水漂流时,组成
“筏子”的工蚁常常会被鱼吃掉,一旦有缺口,
总有其他工蚁义无反顾地补上去,直到蚁团到
达陆地。
组成“筏子”的工蚁为什么宁愿“牺牲”
自己呢?你怎样看待这种现象?
水面上漂动的蚁团
如果你曾仔细观察过像蚂蚁、蜜蜂这类营群体
通过本节学习,你将知道:
◂ 动物的社会行为具有哪 生活的动物,就不难发现,它们群体内部不同成员
些特征? 之间分工合作,共同维持群体的生活。营群体生活
◂ 动物群体中的信息交流 的动物还有猴、狒狒、象和鹿等。它们形成一个社
对动物的生存具有什么
会,具有一系列的社会行为(social behavior)。
意义?
社会行为的特征
白蚁群体成员之间有明确的分工,群体中有蚁
后、蚁王、工蚁和兵蚁。你很容易在蚁群中辨认出
蚁后,它的腹部通常膨胀得很大,是专职的“产卵
机器”。蚁王具有生殖能力,主要负责与蚁后交配。
工蚁承担了觅食、筑巢、照料蚁后产下的卵、饲喂
其他白蚁等大部分工作。兵蚁则专司蚁巢的保卫
(图5-34)。
有些哺乳动物的群体中存在等级。你知道牧羊
人怎样放牧吗?他只需要管好头羊就可以了,羊群中
54 第五单元 生物圈中的其他生物蚁王
蚁后
工蚁
兵蚁
白蚁建造的家园——蚁丘, 蚁
丘通常可高达3米以上。
图5-34 白蚁群体成员的分工
的其他羊都会跟着头羊走。又如,在一群狒狒组成的
“等级社会”中,狒狒之间会根据个体大小、力量强
弱、健康状况和凶猛程度的不同,分成等级次序。作
为“首领”的雄狒狒优先享有食物和配偶,优先选
择栖息场所,其他成员对它会作出表示顺从的姿态,
对它的攻击不敢反击。“首领”也负责指挥整个社群
的行为,并且与其他雄狒狒共同保卫这个群体(图 图5-35 狒狒的群体生活
5-35)。
幼年狒狒
“首领”
雄狒狒 雌狒狒
55从这些例子可以看出,具有社会行为的动物,
群体内部往往形成一定的组织,成员之间有明确的
分工,有的群体中还形成等级。这是社会行为的重
要特征。
群体中的信息交流
群体中的分工合作需要及时交流信息。动物的
动作、声音和气味等都可以起传递信息的作用。例
如,一只黑长尾猴(图5-36)发现蛇时会发出一种
叫声,其他猴会后腿直立并仔细审视地面;而当它
发现豹时会发出另一种叫声,其他猴会立即爬上附
近纤细的树枝;当它发现鹰在天空盘旋时,又会发
出第三种声音,猴群就都聚集到树干附近浓密的树
枝间或窜入茂密的灌木丛。
没有信息交流,动物的个体之间就无法取得联
图5-36 黑长尾猴
系。群体中的信息交流,在群体觅食、御敌和繁衍
后代等方面都具有非常重要的意义。
蚂蚁的通讯
一个动物群体中的某个个体向其他个体发出某种信息,接受信息的
个体产生某种行为反应,这种现象叫作通讯(communication)。
问 题
蚂蚁是怎样进行通讯的?
作出假设
仔细观察过蚂蚁的同学知道,一只蚂蚁发现食物后,会迅速返回巢
穴。不一会儿,一大群蚂蚁排着长长的队伍,“浩浩荡荡”地奔向食物
所在的地点。蚂蚁不会发声,它们是靠什么进行通讯的呢?侦察蚁在食
物和巢穴之间是否留下了什么标记呢?你的假设是
。
56 第五单元 生物圈中的其他生物制订计划
你可以参考下面的探究方案制订自己的探究计划。
(1)利用蚂蚁喜欢吃的食物,诱捕蚂蚁。
(2)如果获取的蚂蚁是用工具从蚁穴里捕获的,就需要将这些受
惊的蚂蚁饲养一段时间,然后再进行实验。实验时最好使蚂蚁处于饥
饿状态。
(3)主要方法和步骤。
❶ 将三块小石头放在盛有少许清水的容器内(如下图),形成三个小
岛,小岛间用两根等长的小木条连接起来,这样蚂蚁只能通过由小
木条搭成的“桥”从一个小岛到达其他的小岛。
❷ 先将饥饿的蚂蚁放在B岛上,食物放在C岛上,A岛什么都不放,观
察蚂蚁的通讯行为。一段时间后再将连接B、C岛之间的“桥”和
A、B岛的对换,观察蚂蚁的行为有什么变化。
C
A
B
❸ 在蚂蚁爬过的“桥”上,涂一些有气味的物质,观察蚂蚁会有什么
样的行为表现。
在制订计划时应当考虑以下问题:捕获的蚂蚁是否来自同一蚁穴?
饲养蚂蚁时需要注意什么?用什么样的木条做“桥”好?“桥”的粗细
和长短对实验有影响吗?实验过程中能否直接用手移动“桥”呢?
通过小组讨论完善探究计划。
实施计划
按修改完善过的探究计划进行实验,认真观察并做好观察记录。
分析结果,得出结论
实验结果是否支持你的假设?你的结论是
。
第二章 动物的运动和行为 57表达与交流
将你的结论与同学交流。你在探究过程中还发现了什么特别有趣的
现象?把你观察到的现象说给同学听。
讨 论
❶ 蚂蚁的通讯是依靠气味,还是依靠触角?还是两者都有呢?你判断
的依据是什么?
❷ 蚂蚁的通讯对它们获取食物有什么意义?
许多动物的个体之间都能进行信息交流。例
如,蝶蛾类昆虫的雌虫,体表的腺体能够分泌吸引
雄虫的物质——性外激素。性外激素是挥发性的物
质,并且具有特殊的气味。雄虫靠触角上的嗅觉感
? 受器感受到同种雌虫性外激素的气味后,就会飞过
来同雌虫交配。用提取的或人工合成的性外激素作
动物的社会行为对动
引诱剂,可以诱杀农业害虫。如果在田间施放一定
物的生存有什么意义?你
能举出其他实例吗? 量的性引诱剂,就会干扰雌雄虫之间的信息交流,
使雄虫无法判断雌虫的位置,从而不能交配,这样
也能达到控制害虫数量的目的。
在自然界,生物之间的信息交流是普遍存在
的。正是由于物质流、能量流和信息流的存在,使
生物之间的联系错综复杂,“牵一发而动全身”,生
物与环境才成为统一的整体。
作出假设,设计实验
不少昆虫有趋向光源的习性。昆虫都有趋光性吗?根据你的生活经
验作出假设,并任选3 ~ 5种昆虫,如家蝇、菜粉蝶、蟑螂、蟋蟀、瓢
虫、蚂蚁等,设计检验这些昆虫是否有趋光性的实验。
58 第五单元 生物圈中的其他生物练习
1. 判断下列说法是否正确。正确的画“√”,错误的画“×”。
(1)利用提取的或人工合成的昆虫性外激素可以诱捕相应的农业害虫。( )
(2)具有社会行为的动物群体中,往往是年长者为“首领”。 ( )
2. 某些动物群体有最占优势者,你能举出例子吗?
3. 同样是肉食动物,虎是单独生活的,狼却往往集结成群捕食猎物。这两种
动物的捕食行为各有什么优势和不足?
4. 除课文中介绍的动物外,你还知道哪些动物的通讯?请你搜集这方面的资
料,与同学交流。
5. 你能说出人类的社会行为与动物的有什么异同吗?
珍妮•古道尔和黑猩猩交朋友
在种类繁多的动物中,与人类亲缘关系最近的是黑猩猩。研究野生
黑猩猩的行为对于研究人类行为的起源和进化具有重要意义。由于野生
黑猩猩生活在非洲茂密的森林中,那里野兽出没,人迹罕至,因此,长
期以来,人们对野生黑猩猩的行为了解很少。19世纪末和20世纪上半
叶,先后有探险家和研究人员前往那里,试图揭开黑猩猩行为之谜。但
第二章 动物的运动和行为 59是,由于野生黑猩猩生性多疑、凶暴,不
易接近,他们始终未能作近距离的细致
观察。直到20世纪60年代,英国姑娘珍
妮·古道尔(Jane Goodall,1934— )自
愿担负起这一艰巨而危险的任务。她只
身前往非洲森林,经过数十年的努力,
收集到许多珍贵的资料,并且与黑猩猩成
了好朋友。
珍妮刚刚来到有黑猩猩出没的森林时,黑猩
猩在500米以外一见她就逃跑,这使她非常苦恼,只能借助望
远镜观察。几个月过去了,一天,一只雄黑猩猩突然来到她帐篷附近的
油棕树上吃果实,这使她非常高兴。于是,她每天上午都坐在帐篷外,
等待这只雄黑猩猩的光临,并给它起了个名字——大卫。有一次,大卫
飞快地下了树,并且不慌不忙地向她走来。当走到离她还有三步远时,
它站住了,毛发耸立起来,样子凶暴可怕。突然,它朝前扑来,从珍妮
面前的桌子上抓起香蕉,然后慌忙跑向一边。这时它的毛发逐渐松垂,
并且安静地吃起香蕉。此后,珍妮一见到大卫就拿出香蕉,大卫对珍妮
不像以前那样惧怕了。后来,大卫又把另一只雄黑猩猩领到珍妮的帐篷
附近,珍妮给这只黑猩猩取名戈利亚……
就这样,珍妮终于能够对好几只黑猩猩进行系统的观察了。她发现
戈利亚是这群黑猩猩中地位较高的。如果其他黑猩猩和戈利亚走近同一
只香蕉,其他黑猩猩总是让戈利亚占先;与其他黑猩猩狭路相逢时,戈
利亚也从来不让路;等等。珍妮还发现黑猩猩能够使用和修整“工具”。
过去人们认为黑猩猩只吃植物,她却多次发现黑猩猩捕杀狒狒、疣猴等
动物。
在研究期间,珍妮与大自然中的黑猩猩朝夕相处,通过仔细观察,
逐渐揭开了笼罩在黑猩猩身上的神秘帷幕。随着研究工作的不断深入,
珍妮在非洲创办了黑猩猩研究中心,越来越多的年轻人来到这里,在珍
妮的带领下从事着黑猩猩的研究和保护工作。
60 第五单元 生物圈中的其他生物第三章
动物在生物圈中的作用
想一想,议一议
羊草是我国北方草原的重要牧草。过
度放牧会使草原退化,那适度的放牧对羊
草的生长有好处吗?
“两个黄鹂鸣翠柳,一行白鹭上青天。”“留连
通过本章学习,你将知道:
戏蝶时时舞,自在娇莺恰恰啼。”在唐代诗人杜甫 ◂ 动物对维持生态系统的
的笔下,动物使大自然充满生机。你想过没有,如 平衡有什么作用?
果没有动物,自然界会是怎样的状况?如果动物的 ◂ 动物在生态系统物质循
环中具有什么作用?
种类和数量锐减,绿色植物会受到影响吗?在生物
◂ 动物对植物的生长、繁殖
圈中,动物具有哪些重要作用呢?
有什么影响?
在维持生态平衡中的重要作用
分析下面的资料。
❶ 20世纪50 ~ 60年代,麻雀因啄食农作物被列为害鸟,我国展开了
“剿灭麻雀”的运动。据有关资料记载,上海市曾在5天内就消灭麻
雀686 172只,获取雀卵265 968只。现在,人们普遍认为应该保护
麻雀。这是为什么?
❷ 呼伦贝尔草原是我国最大的牧业基地。过去那里有许多狼,经常袭
第三章 动物在生物圈中的作用 61击家畜,对牧业的发展构成严重威胁。为了保护人畜的安全,当地
牧民曾经组织过大规模的猎捕狼的活动。但随后野兔却以惊人的速
度发展起来。野兔和牛羊争食牧草,加速了草场的退化。想一想,
野兔数量增加的主要原因是什么?
❸ 某种金合欢有大而中空的刺,蚂蚁栖居其中,并以金合欢嫩叶尖端
的珠状小体为食。蚂蚁“侵食”金合欢,这对金合欢的生长有害
吗?下表是用金合欢幼苗进行实验研究的结果。
金合欢幼苗的生长状况 没有蚂蚁生活的金合欢 有蚂蚁生活的金合欢
10个月中的存活率/ % 43 72
幼苗生长的 5月25日至6月16日 0 6.2 0 31.0
高度/ 厘米 6月17日至8月3日 6.2 10.2 31.0 72.9
讨 论
❶ 通过对以上材料的分析,你认为人类能不能随意灭杀某种动物?为什么?
❷你认为在自然生态系统中,各种动物的数量是否会无限增长?为什么?
❸ 通过对实验数据进行分析,你认为蚂蚁“侵食”金合欢,对金合欢
的生长有害吗?
❹ 从上述资料中,你得到哪些启示?
? 事实表明,在自然生态系统中,各种生物之
间、生物与环境之间存在着相互依赖、相互制约的
你的家乡有没有生态
关系。在生态系统中,生物的种类、各种生物的数
平衡被破坏的例子?
量和所占的比例总是维持在相对稳定的状态,这种
现象就叫作生态平衡(ecological balance)。多种多
样的动物在维持生态平衡中起着重要的作用,人为
捕杀某种动物,或者随意引进某种动物,都会影响
生态系统的平衡状态。
促进生态系统的物质循环
回忆有关生态系统和呼吸作用的知识,想一想,
植物利用二氧化碳和水制造的有机物,是怎样变成
62 第五单元 生物圈中的其他生物二氧化碳和水返回无机环境中的?假如没有动物, ?
有机物变成二氧化碳和水的过程会受到影响吗?
干草堆放久了,会被
动物作为消费者,直接或间接地以植物为食。
分解者逐渐分解,如果被
动物摄取的有机物,有的参与构成动物的身体,有 羊吃了,会在羊体内分解,
的在它们体内经过分解释放能量,供给生命活动的 你认为这两种方式哪种分
解得更快呢?
需要,同时也产生二氧化碳、尿素等物质;动物的
遗体或粪便经过分解者的分解后,也能释放出二氧
化碳、含氮的无机盐等物质,这些物质可以被生产
者利用。可见,动物能促进生态系统的物质循环。
帮助植物传粉、传播种子
自然界中的动物和植物在长期生存与发展的过程
中,形成了相互适应、相互依存的关系(图5-37)。
蜜蜂在汲取花蜜、采集花粉时,身上沾满的花 太阳鸟被誉为“东方的蜂鸟”,在吸食花蜜的同
粉会掉落下来,从而帮助植物顺利传粉。 时,也帮助植物传粉。
苍耳的果实表面有钩刺,可以钩挂在动物的皮 松鼠将收获的松子储存在树洞里、地面下,埋
毛上,被动物带到远方。 在地下的松子在条件适宜时会萌发。
图5-37 动物在植物的繁殖和分布等方面的作用
第三章 动物在生物圈中的作用 63图5-38 飞蝗啃食植物叶片 图5-39 蚜虫吸吮植物的汁液
动物能够帮助植物传粉,使这些植物顺利地繁
殖后代。动物能够帮助植物传播种子,有利于扩大
植物的分布范围。然而,当某些动物数量过多时,
也会对植物造成危害,如蝗灾(图5-38)、蚜虫害
(图5-39)等。
关于动物在生物圈中的作用,你还知道哪些?
请你就这个话题跟同学交流。
练习
1. 判断下列说法是否正确。正确的画“√”,错误的画“×”。
(1)动物直接或间接地以植物为食,这对植物的生长和繁殖总是不利的。( )
(2)没有动物,生态系统的物质循环就无法进行。 ( )
2. 有人说:如果地球上的蜜蜂消失了,地球上便不再有繁茂的植物,不再有
众多的动物,也就可能不再有人的存在。这样的说法是否有一定的道理
呢?为什么?
3. 虫害给农林业生产造成了巨大的损失,为了控制害虫,人们想出了各种办
法,如使用农药,或引入害虫的天敌。这两种方法,你认为哪种好呢?为
什么?
64 第五单元 生物圈中的其他生物动物与仿生
科学家通过对动物的认真观察和研究,模
仿动物的某些结构和功能来发明创造各种仪器
设备,这就是仿生。随着科学技术的迅猛发展,
模仿生物制造出来的新仪器、新设备日益增多。
你能想象出战斗机和长颈鹿有什么联系
吗?战斗机在空中飞行时,需要完成各种各样
的动作,在战斗机突然加速上升过程中,由于
惯性,飞行员体内的血液会往腿部集中,因而脑部供血不足。长颈鹿的
颈这么长,为什么脑部供血不会出现问题呢?科学家通过研究,发现长
颈鹿的血压很高。高血压为什么不会使长颈鹿的心脑血管出现问题呢?
这与长颈鹿身体的结构有关,长颈鹿的皮肤紧致、厚实,紧紧箍住了血
管,起到了保护作用。科学家从中受到启发,研制了飞行服——“抗荷
服”。抗荷服覆盖腹部以下的身体部分,上面安有充气装置,在战斗机
进行特定的动作时,可以充入一定量的气体,将飞行员的腹部、腿部绷
紧,以减缓血液向下肢流动,从而保证脑部供血。
蝴蝶、人造地球卫星,这两者似乎相差很远,但人造地球卫星的控
温系统,却是模拟蝴蝶调节体温的方式设计的。蝴蝶可以利用身体表面
上的小鳞片来调节体温。每当阳光直射、气温上升时,鳞片自动张开,
以减小阳光的辐射角度,从而减少对阳光热能的吸收;当外界气温下降
时,鳞片自动闭合,紧贴体表,让阳光直射鳞片,来增加吸收的热能。
模拟蝴蝶这一调节体温的方式,科学家为人造卫星设计了控温系统,使
卫星上的精密仪器能在外界温度为— 200 ~ 2 000 ℃的环境中正常工作。
仿生学上的发明还有很多。例如,仿照蝇的复眼制造的蝇眼照相机,
模仿蛋壳建造的中国国家大剧院等薄壳建筑,等等。人们还正在模拟人
脑的功能,研制智能化的机器人。想了解更多的仿生学成果吗?建议你
课下收集这方面的资料。
第三章 动物在生物圈中的作用 65第四章
细菌和真菌
当你在大自然中畅游时,映入眼帘的生物大都
是植物或动物,偶尔还会看见蘑菇,它属于真菌
(fungi)。在日常生活中,你还见过馒头变质发霉、
水果上长“毛毛”,那是真菌中的霉菌。至于细菌
(bacteria),肉眼就看不见了。其实,在你周围有
数不清的细菌和真菌,甚至在你的体表和体内也有
许多细菌,有时还会有真菌。
第一节 细菌和真菌的分布
想一想,议一议
这是一幅现代化养鸡场的照片。养
鸡场又不是医院,饲养员为什么要像医
生一样穿着白大褂呢?给散养的鸡喂食
时不用穿白大褂,这又是为什么?
通过本节学习,你将知道: 细菌很小,大部分真菌的个体也比较小,为便
◂ 细菌和真菌的分布范围 于观察和检测,可以在培养皿中加入适于细菌或真菌
是怎样的?
生长的物质,制成培养基来培养。在培养基上,它
◂ 怎样检测环境中的细菌
们会迅速繁殖,形成肉眼可见的菌落(colony)——
和真菌?
66 第五单元 生物圈中的其他生物由一个细菌或真菌繁殖后形成的肉眼可见的集合体
称为菌落(图5-40)。
菌落
图5-40 细菌菌落(左)和真菌菌落(右)
观察菌落
图5-40就是在培养基上生长的菌落,请观察
它们的形态。
细菌的菌落比较小,表面或光滑黏稠,或粗糙
干燥。真菌的菌落一般比细菌菌落大几倍到几十
倍。霉菌形成的菌落常呈绒毛状、絮状或蜘蛛网
状,有时还能呈现红、褐、绿、黑、黄等不同的颜
色。从菌落的形态、大小和颜色,可以大致区分细
菌和真菌,以及它们的不同种类。
科学方法
培养细菌、真菌的一般方法
培养细菌或真菌,首先要配制含有营养物质的培养基。琼脂是一种煮
沸冷却后能胶化成为固态的物质,是制作固体培养基常用的材料之一。将
牛肉汁(或土壤浸出液、牛奶等)与琼脂混合在一起,可以制成培养基。
将配制好的培养基进行高温灭菌冷却后,就可以使用了。将少量细菌或真
菌转移到培养基上的过程叫作接种。通常把接种后的培养皿放在保持恒定
温度的培养箱中,也可以放在室内温暖的地方进行培养。
第四章 细菌和真菌 67探究细菌和真菌的分布
不同环境中都有细菌和真菌吗?你可以通过下
面的活动探个究竟。
检测不同环境中的细菌和真菌
问 题
不同环境中都有细菌和真菌吗?哪种环境中更多一些?哪种环境中
更少一些?哪种环境中根本没有?
探究思路
如果请你帮幼儿园的老师想个办法,让孩子们知道手上就有细菌或
真菌,饭前必须洗手,你有什么办法?
应该将手指上的
要问老师 有了培养基,怎样
配制好培养基, 细菌或真菌接种
怎样配制 才能证明手上有
就可以培养细菌 在培养基上。要
培养基。 细菌和真菌呢?
和真菌了! 不要设置对照?
他们说得有道理吗?请你参照细菌和真菌培养的一般方法,在老师
的帮助下,设计并实施检测不同环境中细菌和真菌的探究活动。各小组
探究的侧重点可以不同,因此问题和假设也可以不一样。重点观察菌落
的形成,并作记录,得出相应的结论。
材料用具
每组两套装有牛肉汁培养基的培养皿(已经高温灭菌)、无菌棉棒、
透明胶带、标签纸、放大镜。
68 第五单元 生物圈中的其他生物!
如果要将装有培养基的培养皿进行高温
灭菌处理,一定要在老师的指导下进行操作。
提 示
● 没有想好如何工作之前,不能打开培养皿。想一想,为什么要有两
套装有培养基的培养皿?各有什么用处?
● 在标签纸上标出组别、实验日期、编号(1号或2号),将标签贴在
培养皿的底面。
● 在各自选定的环境中采集细菌和真菌。例如,在教室或草地、林中、
汽车站旁等地方,打开培养皿,暴露在空气中5 ~ 10分,再盖上,
封好。又如,用无菌棉棒蘸取池水、土壤或擦取口腔内部、手心等
处,在培养基上轻轻涂抹。如果你想检测硬币上有没有细菌,只需
将硬币放在培养基上轻轻按一下。
● 应考虑好放在什么样的环境条件下培养。两套装有培养基的培养皿
都需要在同一环境下培养吗?
● 设计观察记录的表格,计划好观察的时间、次数。
洗手前后培养物的对比(学生作品)
讨 论
❶ 为什么培养用的培养皿和培养基,在接种前必须高温处理?为什么
要用无菌棉棒?
❷ 第3条提示相当于细菌、真菌一般培养方法中的哪一个步骤?
❸ 汇总全班各组的探究结果,你认为细菌和真菌的分布情况是怎样的?
❹ 什么环境条件下不可能有细菌和真菌?在这个探究中,有这样的情
况存在吗?为什么?
❺ 根据你的探究活动进行总结:细菌和真菌的生活必须具有哪些基本
条件?
第四章 细菌和真菌 69在土壤中、水里、空气中乃
至我们的身体上,都可以找到细
菌和真菌。科学家还发现,在寒
冷的极地,在很热的热泉中(图
5-41),也有它们的踪迹。可以
说,细菌和真菌是生物圈中广泛
管状蠕虫
分布的生物。
通过探究活动还可以了解到
细菌和真菌的生存需要一定的条
件,如水分、适宜的温度、有机
物等。有的还要求某些特定的条
件,如有些细菌必须在无氧条件
下生存。
图5-41 深海热泉中的部分生物
深海底部火山口周围的热泉附近,生活着大量的硫
细菌以及管状蠕虫、双壳类、蟹、鱼等生物。
练习
1. 判断下列说法是否正确。正确的画“√”,错误的画“×”。
(1)高温灭菌的培养皿中一般没有细菌和真菌存在。 ( )
(2)由于细菌和真菌都能够形成菌落,所以无法从菌落上区分细菌和真菌。
( )
2. 在下列哪种环境中,霉菌最容易生长?( )
A. 干燥的皮鞋; B. 煮沸但密封的牛肉汁;
C. 潮湿的粮食堆; D. 潮湿的沙土地。
3. 某同学在琼脂培养基上接种了A、B两种细菌进行培养,同时,他还在培养
基上放了盐水浸过的纸片。经过恒温培养一天后,盐纸片周围只有A细菌
生长。你对这个实验结果怎样解释?
4. 你见过泡菜坛吗?制作泡菜的原理就是利用乳酸菌
使蔬菜中的有机物生成乳酸。利用泡菜坛制作泡菜
时,既要给泡菜坛加盖,还要用一圈水来封口,你
能推测其中的科学道理吗?
泡菜坛
70 第五单元 生物圈中的其他生物第二节 细菌
想一想,议一议
破伤风杆菌是一种适于在缺氧条
件下生存和繁殖的细菌,感染人体后
会使人患破伤风。
当伤口较深时(如被铁钉扎伤)容
易得破伤风,而皮肤表面划破一般不
会得破伤风,这是为什么?怎样预防
显微镜下的破伤风杆菌
破伤风?
细菌的发现
通过本节学习,你将知道:
17世纪后叶以前,人们并不知道有细菌这样一 ◂ 细菌具有哪些形态结构
类生物。17世纪后叶,荷兰人列文虎克(Antonie 特征?
van Leeuwenhoek,1632—1723) 制 作 了 能 放 大 ◂ 细菌是怎样进行生殖的?
200 ~ 300倍的显微镜,观察了多种微小的生物。
一次,他把一位从未刷过牙的老人的牙垢,放在显
微镜下观察,吃惊地看到许多小生物。这些小生物
呈杆状、螺旋状或球状;有的单个存在,有的几个
连在一起。他把发现的小生物绘制成图,寄给英
国的皇家学会,发表在学会的会刊上,从此世人
知道了细菌的存在。但直到19世纪中叶,人们仍
不知道细菌是从哪里来的。当时一些著名的科学家
认为细菌是自然发生的。例如,肉汤里就会自然形
成细菌,使肉汤变质。法国科学家巴斯德(Louis
Pasteur,1822—1895)(图5-42)设计了一个巧妙
的实验,证明了肉汤的腐败是由来自空气中的细菌
造成的(图5-43)。1864年7月14日,在法国科学
院的报告厅中,巴斯德展示了他的实验结果,向世
图5-42 被誉为“微生物学之
人证实了细菌不是自然发生的,而是由原来已经存
父”的法国科学家巴斯德
在的细菌产生的。
第四章 细菌和真菌 71鹅颈瓶
一年后 一天后
煮沸肉汤,杀灭 肉汤仍澄清,没 打断瓶颈 肉汤变浑浊,细菌
其中的细菌 有细菌繁殖 在肉汤中繁殖
图5-43 巴斯德的实验
巴斯德还发现了乳酸菌、酵母菌(真菌的一
种),提出了保存酒和牛奶的巴氏消毒法以及防止手
术感染的方法,后人称他为“微生物学之父”。读了
这个故事,你对科学的发现过程有什么新的认识?
细菌的形态和结构
细菌的个体十分微小,大约10 亿个细菌堆积
起来,才有一颗小米粒那么大,只有用高倍显微镜
或电镜才能观察到细菌的形态。虽然细菌种类很
多,但是根据细菌外部形态的不同,大致可以分为
三类:球形的叫作球菌;杆形的叫作杆菌;有些弯
曲的或呈螺旋形的叫作螺旋菌(图5-44)。细菌都
是单细胞的,有些细菌虽然相互连接成团或长链,
但是其中每个细菌都是独立生活的。
球菌(金黄色葡萄球菌, 杆菌(大肠杆菌, 螺旋菌(空肠弯曲
放大16 000倍) 放大4 455倍) 菌,放大3 400倍)
图5-44 电镜下的几种细菌的形态(颜色经人工处理)
72 第五单元 生物圈中的其他生物球菌、杆菌、螺旋菌虽然具有不同的形态,
但是它们的基本结构是相同的。
观察细菌结构示意图,回忆动物细胞和植物细胞的结构,与同学讨
论一下,细菌与动物细胞和植物细胞相比有什么异同。
DNA
鞭毛
细胞质
荚膜
细胞壁
细胞膜
讨 论
❶ 细菌的结构有什么特点?
❷ 试根据细菌的结构推测,细菌能够像植物那样自己制造有机物吗?
说说你的理由。
通过上面的活动可以知道,细菌具有细胞壁、
小资料
细胞膜、细胞质等结构,与动植物细胞的主要区别
荚膜对细菌具有
是,细菌虽有DNA集中的区域,却没有成形的细胞
一定的保护作用,通
核。这样的生物称为原核生物(prokaryotes)。此外,
常与细菌的致病性有
有些细菌的细胞壁外有荚膜,有些细菌有鞭毛。细 关;鞭毛有助于细菌
在液体中游动。
菌没有叶绿体,大多数细菌只能利用现成的有机物
生活,并把有机物分解为简单的无机物,它们是生
态系统中的分解者。
第四章 细菌和真菌 73细菌的生殖
细菌是靠分裂进行生殖的,也就是一个细菌分
裂成两个细菌(图5-45)。分裂完的细菌长大以后
又能进行分裂。在环境适宜的时候,不到半小时,
细菌就能分裂一次。
有些细菌在生长发育后期,个体缩小,细胞壁
增厚,形成芽孢。芽孢是细菌的休眠体,对不良环
图5-45 细菌分裂的电镜照片 境有较强的抵抗能力。小而轻的芽孢还可随风飘散
(放大26 775倍,颜色经人工
各处,落在适宜环境中,又能萌发成细菌。细菌快
处理)
速繁殖和形成芽孢的特性,使它们几乎无处不在。
计 算
假设你手上此刻有100个细菌,细菌的繁殖速度若按每30分繁殖一
代计算,在没有洗手或其他影响细菌生活繁殖的情况下,4小时后你手
上的细菌数目是多少?这对你搞好个人卫生有什么启示?
练习
1. 判断下列说法是否正确。正确的画“√”,错误的画“×”。
(1)细菌与植物细胞最主要的区别是细菌没有细胞壁,有荚膜。 ( )
(2)用放大镜可以观察细菌的结构。 ( )
2. 下列关于细菌生殖的叙述,正确的是:( )
A. 细菌生殖产生的新细菌,与原细菌所含的遗传物质是不同的;
B. 荚膜有保护细菌的作用,与细菌生殖有直接的关系;
C. 细菌靠分裂进行生殖,环境适宜时生殖速度很快;
D. 细菌适应性很强,在不同的环境中有不同的生殖方式。
3. 细菌分布广泛与它们的哪些特点有关?
4. 当咳嗽或打喷嚏时,会把口腔或鼻腔内的液滴喷出2米以外。联系以前学过
的知识,想一想,如果在感冒时对着别人咳嗽、打喷嚏,会对他人带来什
么危害?
74 第五单元 生物圈中的其他生物第三节 真菌
想一想,议一议
图中的蘑菇有根、茎、叶吗?它们的生长是
否需要光?为什么说它们是真菌而不是植物?
各种各样的真菌
通过本节学习,你将知道:
在日常生活中,我们常常看到真菌中的霉菌使 ◂ 生活中常见的真菌有哪些?
食品发霉。其实真菌并不都是有害的,有些霉菌可以 ◂ 真菌细胞的结构具有什
用来制作豆豉、腐乳、酱油等食品,我们平常吃的香 么特点?
◂ 真菌是怎样进行生殖的?
菇、牛肝菌、木耳、银耳等,也是真菌(图5-46)。
除了蘑菇,真菌中也有一些个头小得多的多细
胞的个体(如青霉),还有单细胞的个体(如酵母
菌)。这些真菌具有什么样的结构呢?
图5-46 几种常见的真菌
牛肝菌
银耳
香菇
木耳
75真菌的结构
观察酵母菌和霉菌
目的要求
认识酵母菌、霉菌的形态结构。
材料用具
酵母菌培养液,培养皿中培养好的青霉,吸管,镊子,显微镜,解
剖针,载玻片,盖玻片,放大镜,稀释的碘液,吸水纸。
方法步骤
(1)观察酵母菌
❶ 取一滴酵母菌培养液,滴在载玻片上,盖上盖玻片,用显微镜观察,
就能看到一个个椭圆形的细胞,细胞中有明显的液泡,这就是酵母菌。
❷ 在盖玻片的一侧滴一滴碘液,用吸水纸从另
一侧吸引,对酵母菌进行染色,在显微镜下
能看到酵母菌细胞中染上颜色的细胞核和淀
粉粒。有的细胞上长出大小不一的突起,这
是酵母菌在进行出芽生殖。
(2)观察青霉
❶ 从培养皿中取一块长有青霉的橘子皮,垫上
白纸,用放大镜观察,可以看到一条条直立
生长的白色绒毛,这就是青霉的直立菌丝, 放大2 420倍
菌丝的顶端长有成串的青绿色的孢子。
❷ 用解剖针挑取少许长有孢子的菌丝,制成临
时装片,置于显微镜下观察。注意观察菌丝
有没有颜色,直立菌丝的顶端有没有扫帚状
的结构,以及孢子的着生状态和颜色。
讨 论
❶ 酵母菌的细胞结构有什么特点?
放大685倍
酵母菌(上)和青霉菌(下)
❷ 青霉孢子的颜色和着生状态有什么特点?
电镜照片
76 第五单元 生物圈中的其他生物小资料
通过实验观察可以知道,酵母菌细胞有细胞
冬虫夏草的形成
核,还有细胞壁、细胞膜、细胞质、液泡等。和酵
离不开真菌。这种真
母菌一样,霉菌、蘑菇等真菌的细胞里都有细胞
菌感染蝙蝠蛾幼虫后
核。真菌和动植物都属于真核生物(eukaryotes)。 使幼虫僵化死亡,形
成“冬虫”。到了夏
通过实验还可以观察到,青霉的菌体是由许多
天,真菌再从虫体头
细胞连接起来的菌丝(hypha)构成的(图5-47)。
部生长出棒状的菌体,
每个细胞都有细胞壁、细胞膜、细胞质和细胞核。 形成“夏草”。
组成青霉的菌丝有两种:在营养物质表面向上生长
“夏草”
的,叫直立菌丝;深入到营养物质内部的,叫营养
菌丝。营养菌丝能够从营养物质内吸收有机物,供
霉菌利用。与细菌一样,真菌细胞内也没有叶绿
体,只能利用现成的有机物生活。
孢子
孢子
直立菌丝
营养菌丝 菌盖
发霉的橘子
子
图5-47 青霉的结构图
实
体
蘑菇的菌体也是由菌丝构成的,地下部分是纤
菌褶 菌柄
细的菌丝,能够吸收外界的水分和有机物;地上部
分叫子实体,由菌柄和伞状的菌盖组成。
菌丝
真菌的生殖
蘑菇的结构图
在青霉直立菌丝的顶端,生有绿色的孢子
(spore)。这些孢子可以飘散到各处,每个孢子在适
宜的环境条件下,都能发育成一个新个体。蘑菇也
是用孢子繁殖的。可见,真菌可以通过产生大量的
孢子来繁殖后代。你可以通过下面的制作活动,看
到蘑菇的孢子长在什么部位,数量有多少。
第四章 细菌和真菌 77制作孢子印
孢子印
1. 选取一个较大的新鲜蘑菇,用解剖刀或
解剖剪将菌盖从菌柄上取下来。
2. 把菌褶那面朝下平放在白纸或玻璃板
上,扣上培养皿或玻璃杯,以免散落的孢子被
风吹散。
含孢子印的画(学生作品)
3. 第二天,拿开培养皿(或玻璃杯)和菌
盖,就可以看到在白纸或玻璃板上留下与菌褶
排列一致的放射状孢子印。
4. 孢子印是由菌褶上散落下来的孢子组成
的。用放大镜观察孢子的大小和颜色。
孢子印(学生作品)
练习
1. 判断下列说法是否正确。正确的画“√”,错误的画“×”。
(1)真菌有单细胞的,也有多细胞的。 ( )
(2)真菌细胞内没有叶绿体。 ( )
(3)蘑菇和霉菌一样,也是由大量菌丝构成的。 ( )
(4)霉菌、蘑菇等真菌属于原核生物。 ( )
2. 下面描述的是细菌和真菌的一些特征,请将属于细菌和真菌的特征区分开,
把序号填写在横线上。
细菌的特征是 ,真菌的特征是 。
① 个体微小,细胞内没有成形的细胞核;
② 既有个体微小的种类,也有个体较大的种类,细胞内有成形的细胞核;
③ 能产生孢子,孢子能够发育成新个体;
④ 通过分裂的方式繁殖后代。
3. 夏天,受潮的粮食、衣物和皮鞋常常发霉长毛,这些霉菌是从哪里来的?
为什么霉菌容易在这些物品上生长?
78 第五单元 生物圈中的其他生物第四节 细菌和真菌在自然界中的作用
想一想,议一议
每到冬天,森林里都铺满一层厚
厚的落叶。年复一年,森林里的落叶
层会不会越积越厚呢?为什么?
细菌和真菌虽然个体小,不像动植物那样引人
通过本节学习,你将知道:
注目,但它们在生物圈中的作用却是不可低估的。 ◂ 细菌和真菌是怎样参与生
态系统的物质循环的?
作为分解者参与物质循环 ◂ 细菌和真菌对人和动植
物有哪些影响?
大多数细菌和真菌是生态系统中的分解者。如
果没有分解者,动植物的遗体就会堆积如山。
二氧
分析下列图片中
化碳
展示的生物现象。食
物的腐败现象在日常 二氧
化碳
生活中常能见到,自
然界的物质循环更是
片刻不会停止的。
水和无机盐
水和无机盐
生物遗体
真菌和细菌
面包发霉
真菌、细菌在物质循环中的作用示意图
第四章 细菌和真菌 79讨 论
❶ 面包发霉后,其中的有机物被分解成什么物质?
❷ 细菌和真菌在物质循环中起什么作用?
在自然界的物质循环中,细菌和真菌能够把动
植物遗体分解成二氧化碳、水和无机盐,这些物质
又能被植物吸收和利用,进而制造有机物。由此可
见,细菌和真菌对于自然界中物质的循环起着重要
的作用。
引起动植物和人患病
细菌和真菌中有一些种类是寄生生活的,它们
能够从活的动植物体和人体内吸收营养物质,导
致动植物和人患不同的疾病。例如,链球菌可以
使人患扁桃体炎、猩红热、丹毒等多种疾病(图
5-48);一些真菌寄生在人的体表或体内,引起人
患手癣、足癣等疾病(图5-49) ;棉花枯萎病、水
稻稻瘟病、小麦叶锈病、玉米瘤黑粉病等植物疾
病,都是由真菌感染引起的(图5 -50)。
图5-48 电镜下的链球菌(放
大6 000倍,颜色经人工处理)
图5-49 手癣 图5-50 小麦叶锈病(左)和玉米瘤黑粉病(右)
80 第五单元 生物圈中的其他生物与动植物共生
有些细菌和真菌与动物或植物共同生活在一
起,它们相互依赖,彼此有利,这种现象叫作共生
(symbiosis)(图5-51,图5-52)。
图5-52 豆科植物的根瘤
图5-51 地衣
大豆、花生等属于豆科植物。
生长在旧墙壁、树干或岩石上,呈灰绿色、硬
在豆科植物的根瘤中,有能够
壳状的植物斑块就是地衣。实际上,地衣是真
固氮的根瘤菌与植物共生。根
菌与藻类共生在一起而形成的。藻类通过光合
瘤菌将空气中的氮转化为植物
作用为真菌提供有机物,真菌可以为藻类提供
能吸收的含氮物质,而植物则
水和无机盐。
为根瘤菌提供有机物。
除了上面谈到的细菌、真菌与植物的共生现象
外,细菌、真菌与动物的共生现象也很普遍。例
如,在牛、羊、骆驼等食草动物的胃肠内,生活着
一些细菌,可以帮助动物分解草料中的纤维素,而
动物又可以为这些细菌提供生存的场所和食物,它 ?
们彼此依赖,共同生活。你自己的肠道中也有多
过多服用抗生素会对
种多样的细菌,大部分是正常菌群,对人体没有危
肠道内正常菌群产生什么
害,其中有些细菌还能够制造维生素B 和维生素 影响?
12
K,对你的健康很有益处。人体肠道内的细菌,可
随粪便排出体外,几乎占粪便干重的一半。
第四章 细菌和真菌 81评价实验方案
为证明细菌对植物遗体的分解作用,某小组的同学分别提出三种实
验方案。三种方案的共同点是:将同一种树的落叶分成甲乙两组。实验
过程中滴加蒸馏水,使树叶保持潮湿。
方案1 将甲组放在无菌条件下,乙组放在自然条件下(暴露在空气中)。
方案2 将甲组灭菌后放在无菌条件下,乙组放在自然条件下。
方案3 将甲乙两组都进行灭菌处理,甲组放在无菌条件下,乙组接
种细菌后放在无菌条件下。
讨 论
❶ 甲乙两组为什么要用相同的树叶?
❷ 为什么要使树叶保持潮湿?
❸ 哪个方案更能说明问题?为什么?
练习
1. 判断下列说法是否正确。正确的画“√”,错误的画“×”。
(1)绝大多数细菌和真菌能将有机物分解成无机物,是生态系统中的分解
者。 ( )
(2)只要有细菌和真菌存在,人和其他动植物就会生病。 ( )
(3)一些细菌生活在牛、羊胃肠内,不但不引起牛、羊患病,还对牛、羊
有好处。 ( )
2. 细菌将动植物遗体中的有机物分解为二氧化碳和水,这一生理过程属于: ( )
A. 光合作用; B. 呼吸作用; C. 蒸腾作用; D. 吸收作用。
3. 在农业生产中,人们常常通过种植豆科植物来提高土壤肥力,从而提高农
作物的产量。这是为什么?
4. 有些细菌和真菌可以寄生在动植物体内,使它们患病;有些细菌和真菌却
能够与动植物共生。那么,我们应该怎样看待细菌和真菌与动植物之间的
关系呢?
82 第五单元 生物圈中的其他生物以菌治虫
1911年,德国人在一个叫作苏云金的地方,
发现了一种寄生在昆虫体内的细菌,具有很强的
杀虫能力,人们称这种细菌为苏云金杆菌。苏云
金杆菌在一定条件下能够形成芽孢和伴胞晶体。
伴胞晶体是一种毒性很强的蛋白质晶体,能使某些害虫瘫痪致死。芽孢
能通过昆虫破损的消化道进入血液,在血液中大量繁殖,使害虫死亡。
现在人们已经能够大规模地培养苏云金杆菌,并将其制成粉剂或液剂,
在需要时将它们喷洒到林木和农作物上,用来杀灭害虫。苏云金杆菌对
松毛虫、玉米螟、菜青虫、棉铃虫等100多种害虫都有毒杀作用。
目前已经知道,有多种真菌具有杀虫本领,白僵菌就是其中重要的
一种。白僵菌分布广,杀虫力强,松毛虫、玉米螟、大豆食心虫、甘蔗
象鼻虫等害虫,感染上白僵菌后,三天左右就会僵化而死。
苏云金杆菌和白僵菌的利用已在我国推广。利用细菌和真菌作为生
物杀虫剂,不仅可以控制害虫数量,同时也能通过减少农药的使用,减
轻对环境的污染。
白僵菌的菌丝自害虫体内钻出
(电镜照片,图中白色带状物
为菌丝)
第四章 细菌和真菌 83第五节 人类对细菌和真菌的利用
想一想,议一议
作为清洁能源,沼气越来越受到
人们的重视。生产沼气的原料是人粪
尿、禽畜粪尿和农作物秸秆,为什么
沼气罐
它们在沼气池中能够产生沼气呢?
一提到细菌和真菌,人们往往只想到它们的害
通过本节学习,你将知道:
◂ 细菌和真菌与食品的制 处,如引起疾病和使食物变质。其实,很多细菌和
作及保存有什么关系? 真菌对人类是有益的。
◂ 细菌和真菌与人类防治
疾病有什么关系?
细菌、真菌与食品的制作
◂ 细菌在清洁能源和环境
许多食品的制作都要利用细菌或真菌。
保护中的作用有哪些?
发酵现象
在一杯温开水中加入一大勺糖和一小包酵
母,进行搅拌。将这个杯子中的液体倒入透明
的玻璃瓶或矿泉水瓶内,再往瓶内加一些温开
水。将一个小气球挤瘪后套在瓶口。将瓶子放
在教室内窗台上,观察瓶中的情况,看看瓶中
的液体会不会冒出气泡,气球会不会胀大。
右图是某学生的实验结果。你能对实验现
象作出解释吗?
有的真菌如曲霉的体内含有大量的酶,可以把
淀粉分解为葡萄糖;有的真菌如酵母菌可以把葡萄
糖转化为酒精并产生二氧化碳。有的细菌如乳酸菌
84 第五单元 生物圈中的其他生物含有的酶则能够把葡萄糖转化为乳酸。制作馒头或
面包时,酵母菌产生的二氧化碳气体会在面团中形
成许多小孔,使馒头或面包膨大和松软,而面团中
所含的酒精,则在蒸烤过程中挥发掉了。乳酸菌能
使牛奶变成酸奶,使蔬菜变成有酸味的泡菜。另外
制醋要用醋酸菌,制酱要用多种霉菌。可见,由于
利用细菌和真菌,人类的食品更加丰富多彩了(图
5-53)。
现在酿酒可以用酒曲(制酒用的菌种),做馒
图5-53 利用细菌和真菌制作的食品
头或面包可以用干酵母,这些都能在市场上买到。
你不妨在家长帮助下,自己尝试着制作米酒。
制作米酒
材料用具
酒曲一块,糯米1 500克,凉开水一杯,清洁的容器、蒸锅、筷子,
洁净的蒸布。
方法步骤
(1)将糯米放在容器中用水浸泡一昼夜,把米淘洗干净。
(2)在蒸锅的笼屉上放上蒸布,将糯米倒入,铺平,盖好锅盖。置
于旺火上蒸熟。将蒸熟的米饭用凉开水冲淋一次。放置到用手触摸微热
(30 ℃)的时候,装入清洁的容器中。
(3)将酒曲碾碎成粉末,撒在糯米饭上,并迅速将酒曲与微热的糯
米饭均匀地搅拌在一起,然后将糯米饭压实,中间挖一个凹坑,最后淋
上一些凉开水。
(4)把容器盖好,并采取一定的保温措施,如用毛巾将容器包裹起来。
(5)将容器放在温暖的地方,冬天可放在暖气旁,以提高温度。
提示
● 制作米酒的工具以及整个操作过程要保持清洁、切忌油腻。
● 根据酒曲包装上的说明(或请教有经验的人),按照一定比例将酒曲
第四章 细菌和真菌 85与糯米饭搅拌。
● 在制作米酒的过程中,尽量少打开容器,以防止其他细菌和真菌的
污染。
● 一般在冬季制作米酒要用3天左右。当你打开容器,闻到酒香,看到
米粒呈柔软状,食用时微甜而不酸,就说明米酒的制作已经成功了。
附:如果你感兴趣的话,还可以试着制作酸奶。酸奶的制作过程比
较简单,制作时应注意购买低温储存的带活菌种的酸奶,原料奶、酸奶
的混合比例应恰当,可加入蔗糖调节酸奶的味道,容器放在温暖的地
方,另外注意制作工具和操作过程的干净卫生。赶快试试吧!
细菌、真菌与食品的保存
食品的腐败主要是由细菌和真菌引起的,这些
细菌和真菌可以从食品中获得有机物,并在食品中
生长和繁殖,导致食品的腐败,因此食品保存中的
一个重要问题就是防腐。
防止食品腐败可以采用不同的方法。观察
右面的图片,联系生活经验回答下面的问题。
讨 论
❶ 图中有几种保存食品的方法?
❷ 试着说出其中一些方法所依据的原理。
❸ 除上述的方法外,你还知道哪些方法可以防止食品腐败?
防止食品腐败所依据的主要原理是把食品内的
细菌和真菌杀死或抑制它们的生长和繁殖。你可以
仔细阅读不同食品的标签或包装说明,这样就可以
知道更多保存食品的方法。
86 第五单元 生物圈中的其他生物细菌、真菌与疾病防治
细菌和真菌可以引起多种疾病,但有些
真菌却可以产生杀死或抑制某些致病细菌的
物质,这些物质称为抗生素(antibiotic)。抗
生素可以用来治疗相应的疾病。现在,科学
家还能用现代技术手段,把其他生物的某种
基因转入一些细菌内部,使这些细菌能够生 图5-54 胰岛素生产车间
科学家把控制合成胰岛素的基因转
产药物(图5-54)。
入大肠杆菌内,对大肠杆菌进行
培养,使之生产治疗糖尿病的药
细菌与清洁能源和环境保护 物——胰岛素。
农作物秸秆、人粪尿和禽畜粪尿中,有
很多有机物。在没有氧气的环境下,甲烷菌
利用这些有机物分解产生的氢,和二氧化碳
结合生成甲烷。甲烷是一种清洁能源,可作
为燃料用于做饭、照明、取暖等。还有一些
细菌也能利用这些有机物生存,使有机物进
一步分解。城市的污水处理厂可以根据其中
的原理,利用细菌来净化生活污水或工业废
水(图5-55)。 图5-55 污水处理厂
练习
1. 判断下列说法是否正确。正确的画“√”,错误的画“×”。
(1)制作不同的发酵食品,所利用的真菌或细菌可能是不同的种类。 ( )
(2)腌肉长时间不易腐烂,是由于盐分多会抑制细菌的生长。 ( )
2. 下列关于抗生素的叙述,正确的是:( )
A.抗生素只能杀死致病细菌,不会杀死其他细菌;
B.抗生素能杀死细菌,因此抗生素药品不会腐败变质;
C.生病时应尽早服用抗生素,以便早日康复;
D.抗生素虽能治病,但使用不当也会对身体不利。
3. 有些化学物质能防止由细菌、真菌引起的食物腐败,这些物质称为防腐剂。
近年来,科学家证实食用过多的防腐剂对健康有害,因此,要少食用含有防
腐剂的食品。注意查看所买食品包装上的说明,看看使用了哪些防腐剂。
第四章 细菌和真菌 87“超级细菌”近在咫尺
1928年,英国的细菌学家弗莱明
(Alexander Fleming, 1881—1955)在
研究细菌时,发现了青霉能够产生一
种杀死或抑制细菌生长的物质,他把
这种物质叫作青霉素。在第二次世界
大战中,青霉素作为治疗细菌感染的
药物,拯救了成千上万伤病员的生命。
青霉素的研制成功,极大地激发了人
们探索新型抗菌药物的兴趣,此后也
不断有新的抗生素问世。
20世纪中叶抗生素刚开始使用时,人们认为它既能有效地杀灭病菌
还对人体无害。于是,抗生素不但在临床上应用越来越广,甚至在禽畜
饲养和农作物栽培过程中也广泛使用。随着抗生素被滥用,人们发现,
有些病菌不再“害怕”抗生素了,原来用抗生素很容易控制的结核杆
菌、金黄色葡萄球菌等病菌,已经对多种抗生素产生了耐药性。人们就
称那些对绝大多数抗生素不再敏感的细菌为“超级细菌”。
事实上,所有的超级细菌都是由普通细菌变异而成的。我们知道,
细菌在生长和繁殖过程中,可能会产生少数的耐药菌。本来少数耐药菌
在细菌群体中并不突出,但是,由于人类滥用抗生素,抗生素在杀死普
通细菌时却留下了耐药细菌,而且随着抗生素的持续滥用,耐药菌的耐
药性越来越强。于是,各种超级细菌诞生了。过去一个病人用几十单位
的青霉素就能治愈,而相同病情,现在用几百万单位的青霉素也可能没
有效果。不断出现的超级细菌致死案,引发了人们对如何科学使用抗生
素药物的反思。
抗生素的研制和使用使亿万人受益,但是滥用抗生素也带来严重的
后果。读了这篇短文,你对科学、技术和社会的关系有什么新的认识?
88 第五单元 生物圈中的其他生物第五章
病毒
想一想,议一议
艾滋病病毒
右图是艾滋病病毒侵入细胞的电
细胞膜
镜照片(放大70 000倍)。比较一下病
毒和细胞在形态大小方面的差异,推
测病毒的结构与细胞有什么不同? 细胞
19世纪末,俄国科学家伊万诺夫斯基(Dmitri
通过本章学习,你将知道:
Ivanovsky, 1864—1920)在研究烟草花叶病(图 ◂ 病毒的结构有什么特点?
5-56)的病因时,推想这种病是由细菌引起的。 ◂ 病毒是怎样繁殖的?
他将患花叶病的烟草榨出汁液,用能将细菌滤去的 ◂ 病毒与人类的生活有什
么关系?
过滤器进行过滤,再用过滤后的汁液去感染正常的
烟叶,结果发现正常的烟叶还能患病。这表明烟草
花叶病是由比细菌还小的病原体引起的。科学家把
这种病原体叫作“滤过性病毒”。后来,其他科学
家在研究动物的口蹄疫病时,证明了口蹄疫也是由
“滤过性病毒”引起的。随着科学技术的进步,在
20世纪初,科学家首次用电子显微镜观察到烟草花
叶病毒是一种杆状颗粒。
图5-56 烟草正常叶(左)
和烟草花叶病病叶(右)
第五章 病毒 89病毒的种类
由于科学家的工作,现在我们知道人类的流行
性感冒、艾滋病,动物的口蹄疫、鸡瘟,植物的烟
草花叶病、萝卜花叶病,等等,都是由病毒(virus)
感染引起的疾病。在电子显微镜下,可以看到病毒
的形态是多种多样的(图5-57)。它们比细菌小得
多,只能用纳米(百万分之一毫米)来表示它们的
大小。
烟草花叶病毒 腺病毒 大肠杆菌噬菌体
(放大300 000倍) (放大500 000倍) (放大450 000倍)
图5-57 电子显微镜下的病毒
病毒不能独立生活,必须寄生在其他生物的细
胞内。根据它们寄生的细胞不同,可以将病毒分为
三大类:专门寄生在人和动物细胞里的动物病毒,
如流感病毒(图5-58);专门寄生在植物细胞里的
植物病毒,如烟草花叶病毒;专门寄生在细菌细胞
内的细菌病毒,也叫噬菌体,如大肠杆菌噬菌体。
图5-58 流感病毒模式图
病毒的结构和繁殖
病毒的结构简单,由蛋白质外壳和内部的遗传
物质组成,没有细胞结构(图5-59)。病毒只能寄
生在活细胞里,靠自己的遗传物质中的遗传信息,
利用细胞内的物质,制造出新的病毒,这是它的繁
殖方式。新生成的病毒又可以感染其他活细胞。病
90 第五单元 生物圈中的其他生物毒要是离开了活细胞,通常会变成结晶体。当外界
环境条件适宜时,病毒便侵入活细胞,生命活动就
会重新开始。
蛋白质
遗传物质 内有遗传物质
内有遗传物质
蛋白质 蛋白质
烟草花叶病毒 腺病毒 大肠杆菌噬菌体
图5-59 病毒结构示意图
小资料
在呼吸道传染病
病毒与人类生活的关系
流行时,应避免去人
病毒的种类很多,在生物圈中分布广泛,又
多拥挤的地方;外出
营寄生生活,给人类、饲养动物、栽培植物带来 应正确佩戴口罩,应
极大危害。例如,由病毒引起的流行性感冒、严 及时并正确地洗手;
平时注意开窗通风,
重急性呼吸综合征(曾称传染性非典型肺炎)、
采用分食制等,以减
肝炎、手足口病、埃博拉出血热等,严重危害人
少感染的机会。
体健康。被称为世纪瘟疫的艾滋病,就是由病毒
引起的,人类至今尚未找到彻底治愈的方法。肆
虐全球的新冠肺炎也是由病毒引起的。口蹄疫、
禽流感(图5-60)以及众多的植物病毒病,给农
牧业生产造成巨大损失。
禽流感是指由禽流感病毒引起的禽类急性传
染病。主要发生在鸡、鸭、鹅、鸽等禽类,引起
从呼吸系统异常到严重的全身败血症等多种症
状。按病原体的类型,禽流感可分为高致病性、
低致病性和非致病性三大类。高致病性禽流感传
播快、危害大,我国将其列为一类动物疫病。 图5-60 扑杀患禽流感的病鸡
第五章 病毒 91虽然病毒常常令人谈“毒”色变,但是人类在
小资料
研究病毒的过程中,也取得了可喜的成果。人们一
口蹄疫是由口蹄
方面设法治疗和预防病毒性疾病,一方面利用病毒
疫病毒引起的一种急
为人类造福。人们用接种牛痘疫苗的办法,预防由
性传染病,感染对象
主要是牛、猪、羊等 天花病毒引起的天花,已经使这种病在世界范围内
家畜,人也可感染。
消失。脊髓灰质炎又叫小儿麻痹症,在我国由于
主要症状是口和足等
口服疫苗的普遍使用,已经得到控制。口蹄疫、禽
处的黏膜、皮肤先出
流感等动物病毒病也可以通过接种疫苗的方法进行
现红点、水疱,然后
溃烂,严重时引起死 防治。这些疫苗就是经过人工处理的减毒的或无毒
亡。
的病毒。科学工作者还在寻找利用某些病毒防治有
害生物的方法。在基因工程中,小小的病毒能帮大
忙。科学家能够让某些病毒携带动植物或微生物的
某些基因进入受体细胞,来达到转基因或基因治疗
的目的。
练习
1. 判断下列说法是否正确。正确的画“√”,错误的画“×”。
(1)病毒没有细胞结构,不能独立生活。 ( )
(2)病毒的个体很小,要用电子显微镜才能观察到。 ( )
(3)病毒一旦侵入人体,就会使人患病。 ( )
2. 完成下面的图解。
大小 观察工具
种类 生活方式
病毒
结构 繁殖方式
3. 口蹄疫、禽流感、烟草花叶病都属于病毒导致的动植物疫病,还有哪些类
型的动植物疫病?有些动植物疫病会跨境传播,危害极大。如何防止它们
跨境传播?请搜集这方面的资料,并与同学交流。
92 第五单元 生物圈中的其他生物狂犬病和狂犬病病毒
你一定听说过狂犬
病吧!这种传染病的病
死率很高。全世界每年
有数万人死于狂犬病。
狂犬病是由狂犬病病毒
引起的。
狂犬病病毒能在野
生动物如狼、狐、鼬鼠、
蝙蝠,家养动物如狗、
猫、牛,以及人之间传
给狗注射狂犬病疫苗
播。人在被携带狂犬病
病毒的动物咬伤后,就
狂犬病病毒电镜照片
可能感染狂犬病病毒。 (放大150 000倍)
感染病毒后,潜伏期一般为1 ~ 2个月,短者5 ~ 10天,长者数年。
在发病前数日,病毒从脑内和脊髓沿神经进入唾液腺内增殖,不断随唾
液排出。人发病时,先感不安,伴随头痛、发热,侵入部位有刺痛或出
现蚁走的异常感觉,继而出现心跳加快、出汗、流涎、多泪、瞳孔放
大,吞咽时咽喉肌肉发生痉挛,最后转入麻痹、昏迷、呼吸及循环衰竭
而死亡,病程大约5 ~ 7天。
狂犬病一旦出现症状,死亡率几乎达到100%。唯一的预防措施是在
被动物咬伤前或咬伤后及时注射狂犬病疫苗。被狗、猫等动物咬伤后,
如果不能确定动物是绝对健康的,就应该尽快到医院诊治。
为了你和他人的健康,饲养的猫、狗等宠物,一定要在相应机构注
射狂犬病疫苗。
第五章 病毒 93单元小结
在生物圈中,除了绿色植物和人以外,还有形形色色的动物,各种各
样的细菌和真菌,以及不具备细胞结构的病毒。作为消费者的动物,作为
分解者的细菌和真菌,在生物圈的物质循环和能量流动中各有其重要作
用,与人类的生存和发展有着非常密切的关系。
本单元综合运用了观察、实验、培养、检测、制作、资料分析等多种
探究方法,课外实践活动丰富多彩,通过这些活动,可以提高动手能力和
实践能力。
通过本单元的学习,对以下重要概念加深了理解。
● 根据动物在形态结构等方面的特征,可以将动物分为不同的类群,
如腔肠动物、扁形动物、线形动物、环节动物、软体动物、节肢动物等无
脊椎动物,以及鱼、两栖动物、爬行动物、鸟和哺乳动物等脊椎动物。各
个类群的动物具有不同的特征,与人类的生活有着密切的关系。
● 自由运动是动物区别于其他生物的重要特征之一。就哺乳动物而
言,动物的运动主要是由骨、关节和肌肉共同完成的,还需要其他系统如
神经系统的调节。运动要消耗能量,运动所需能量的供应,离不开消化系
统、呼吸系统、循环系统等系统的协调配合。
● 动物的行为是指动物所进行的有利于它们生活和繁殖后代的活动。
有些行为是动物生来就有的,是由遗传物质决定的;有些行为是在遗传
因素的基础上,通过后天生活经验和学习形成的,这两类行为具有不同的
适应意义。
● 真菌和大多数细菌有着相似的营养方式,都是利用现成的有机物获
取生命活动所需的物质和能量。细菌和真菌属于不同的类群,它们具有不
同的形态结构和繁殖方式。例如,细菌没有成形的细胞核,而真菌具有成
形的细胞核;细菌靠分裂进行生殖,而真菌可以通过产生孢子来繁殖。
● 病毒结构简单,仅由蛋白质外壳和内部的遗传物质组成,不能独立
生活,只能寄生在活细胞内,并在寄主细胞内进行繁殖。
94 第五单元 生物圈中的其他生物第六单元
生物的多样性及其保护
大熊猫是我国的国宝,它的数量非常稀少!
数量稀少的何止大熊猫!白鳍豚已踪迹难寻,朱鹮、东北
虎、银杉……它们的生存都面临着严重的威胁!
多种多样的生物是生态系统的重要成员,是一座座独特的基
因库,是我们在这颗美丽而孤独的星球上生存的伙伴。
我们不能眼睁睁地看着它们从地球上消失!第一章
根据生物的特征进行分类
我们知道,书籍在书架上要分类摆放,这样才
便于查阅。同样,了解生物的多样性,保护生物的
多样性,都需要对生物进行分类(classification)。
第一节 尝试对生物进行分类
想一想,议一议
如果你想了解菜粉蝶的生长发育和行为,在
这几本书中,你会选择查阅哪一本?要是想了解
蛾、青蛙的相关资料,又该查阅哪几本呢?
通过上面的“想一想,议一议”活动,你应该
通过本节学习,你将知道:
◂ 对生物进行分类的依据 对分类的意义有所了解了吧。我们已经学习了生物
是什么? 圈中的植物、动物、细菌、真菌等生物类型,怎样
◂ 怎样根据生物的特征对
对这些类型的生物做进一步的分类呢?让我们以常
生物进行分类?
见的一些生物为例,试着将它们进行分类,做一个
小小的分类学家。
96 第六单元 生物的多样性及其保护植物的分类
认真观察下列图片,并阅读表解。
葫芦藓
向日葵
水绵 肾蕨
玉米
植物
油松
有种子 无种子
种子有果皮包被 种子无果皮包被 有茎叶 无茎叶
叶脉为平行脉 叶脉为网状脉 有根 无根(假根) 无根
(一片子叶) (两片子叶)
A类植物 B类植物 C类植物 D类植物 E类植物 F类植物
讨 论
❶ 图片中的植物分别属于A、B、C、D、E、F中的哪类植物?
❷ A、B、C、D、E、F各类植物都属于同一分类等级吗?
❸ 有种子的植物可以分为哪些类群?
❹ 无种子的植物可以分为哪些类群?
❺ 你能否把上述植物的所属类群按一定顺序(如从简单到复杂)排列?
❻ 通过上面的分析,你认为植物分类考虑了植物的哪些特征?
第一章 根据生物的特征进行分类 97通过前面的活动可以发现,生物学家在对植物
进行分类时,要仔细观察植物的形态结构,如被子
植物的根、茎、叶、花、果实和种子的形态结构,
从这些器官中发现它们共同的或不同的特征,从而
确定它们的亲缘关系。在被子植物中,花、果实和
种子往往作为分类的重要依据。现在,你该对植物
的分类有一个初步的了解了吧。
动物的分类
观察下面的图片。
岩蜥
螳螂 草原雕
蜗牛
鱼
蝴蝶
蚯蚓
涡虫 雨蛙
虎
98 第六单元 生物的多样性及其保护讨 论
❶ 将这10种动物分为两组,应该如何划分?每组里有哪些动物?
❷ 将每组中的动物再进行分类,又可以分为哪几类?每类有哪些动物?
❸ 你能尝试仿照植物分类的表解方式,将这10种动物列入表中相应的
位置吗?
❹ 请把不同的动物类群按照从简单到复杂的顺序排列起来。
❺ 尽量把你所认识的其他动物列入上面的不同类群中,看谁写得又多
又快又正确。
动物的分类除了要比较形态结构,往往还要比
较动物的生理功能。
细菌、真菌等其他生物的分类,也需要根据它
们的特征来进行。例如,根据不同真菌形态结构的
特征,可以将真菌分为酵母菌、霉菌等类群。
分 类
分类的技能不仅在科学探究中
有用,在工作和生活中也经常用
到。现在,假设你在一个食品店工
作,需要将各种食品分类摆放在货
架上,怎样进行分类才能让你和顾
客都容易找到某种食品呢?
你可以运用这节课学到的分类
方法,按照食品之间的共性和差异,列出3 ~ 5大类食品,如肉、蛋、
奶、点心、调味品等,然后参考下面的对调味品分类的示例,对某一大
类食品作进一步分类。
第一章 根据生物的特征进行分类 99调味品
非包装 包装
瓶装 非瓶装
袋装 桶装
蒜 姜 蚝油 芥末油 香油 糖 味精 盐 酱油 醋
将你的分类结果与其他同学的进行比较,讨论各自分类方案的优缺
点。你所用的分类方法与生物的分类方法有什么相似之处?
练习
1. 判断下列说法是否正确。正确的画“√”,错误的画“×”。
(1)被子植物的根、茎、叶、花、果实、种子的形态结构都可以作为分类
的依据。 ( )
(2)动物的分类除了要比较形态结构,往往还要比较生理功能。 ( )
2. 在被子植物中,花、果实和种子往往作为分类的重要依据,请你试着分析
一下科学家这么做的原因。
3. 试就下表中每一项特征,写出相应的植物或动物类群名称,并分别举例写
出1~3种植物或动物的名称。
特 征 类群的名称 举 例
有花,两片子叶,
叶脉一般为网状脉
不具根、茎、叶
无花,种子裸露
身体表面有角质鳞片或甲,
卵生,体温不恒定
胎生,哺乳
100 第六单元 生物的多样性及其保护第二节 从种到界
想一想,议一议
蜜蜂既是动物、无脊椎动物、
节肢动物,又是昆虫。同一种动物
为什么要冠以不同的类群名称呢?
为了科学地将生物进行分类,弄清生物之间的
通过本节学习,你将知道:
亲缘关系,生物学家根据生物之间在形态结构和生 ◂ 生物分类有哪几个等级?
理功能上的相似程度,把它们分成不同等级的分类 ◂ 对生物进行分类具有什
单位。生物可分为植物界、动物界等几个界,每 么意义?
个界下面又被分为几个不同的门,依此类推。生
物分类从大到小的等级依次是:界、门、纲、目、
科、属、种(species)。例如,植物界中有若干个
门,每个门的所有植物都有一些共同特征;在一个
门里,可能会有成百上千种生物,但是在每一个种
里,只有一种生物(一种生物便是一个物种)。因
此,“种”是最基本的分类单位,同种生物的亲缘
关系是最密切的。
科学方法
生物分类
生物分类是研究生物的一种基本方法。生物分类主要是根据生物的相
似程度(包括形态结构和生理功能等),把生物划分为种和属等不同的等
级,并对每一类群的形态结构和生理功能等特征进行科学的描述,以弄清
不同类群之间的亲缘关系和进化关系。
下面让我们看一看狼是怎样被列入不同等级的
分类单位的(图6-1)。
第一章 根据生物的特征进行分类 101102 第六单元 生物的多样性及其保护种
每一只狼是一个动物个体,但所有的狼都属于同一
个物种。
属
郊狼的体型比狼小得多,但是这两种动物都具有身
体较长、眶间部显著隆起等特征,因此它们被划分
到同一个属——犬属。
科
狐的眶间部平缓,但它与狼、郊狼都具有颜面部较
长、吻端突出、爪钝而不能伸缩等共同的特征,因
此被划分到同一个科——犬科。
目
虎的爪锐利且能伸缩,不属于犬科,但它和狼、郊
狼、狐一样,具有尖锐的犬齿,因此它们同属于食
肉目。
纲
马、兔、蝙蝠等动物,与狼、郊狼、狐之间的差别
很大,但它们都具有胎生、哺乳等特征,都属于哺
乳纲。
门
图中的这些动物都有脊椎骨构成的脊柱,它们同属
于脊索动物门的脊椎动物亚门。
图6-1 狼在动物分类中的位置
第一章 根据生物的特征进行分类 103小资料
从上图可以看出,狼这个物种,在分类上隶属
动物界包括腔肠
于犬属、犬科、食肉目、哺乳纲、脊索动物门的脊
动物门、扁形动物门、
椎动物亚门、动物界。这样,狼在生物分类上的位
线形动物门、环节动
物门、软体动物门、 置就一目了然了。
节肢动物门、脊索动
同样,植物的每一个物种,也可以用同样的方
物门等门。脊索动物
法,归属于相应的属、科、目、纲、门、界之中。例
门包括尾索动物亚门、
头索动物亚门和脊椎 如,桃在分类上隶属于桃属、蔷薇科、蔷薇目、双子
动物亚门。脊椎动物 叶植物纲、种子植物门的被子植物亚门、植物界。
亚门包括鱼纲、两栖
像这样,生物学家按照不同等级的分类单位对
纲、爬行纲、鸟纲和
生物进行分类,可以弄清生物之间的亲缘关系,更
哺乳纲等。
好地研究各种生物。
练习
1. 在界、门、纲、目、科、属、种的七个等级中,你认为哪个等级的生物的
共同特征最多?哪个最少?说出你的理由。
2. 蝙蝠会飞,但在分类学上属于哺乳纲,而不属于鸟纲,请你说出其中的原因。
3. 在植物园或公园里,经常可以看到各种植物的标牌。标牌上写着植物的名
称、属于哪个科、分布和用途等。标牌上的外文字是拉丁文,前面是属名,
后面是种加词,表示该种植物的国际通用名称。在老师的指导下,查阅有
关分类的书籍,试着给校园内的植物挂上标牌。
月 季
Rosa chinensis Jacquem.
俗称月月红,又名长春花、
月月花等,蔷薇科。原产
中国,其特点是从春到秋
Rosa chinensis Jacquem. 蔷薇科
开花不绝,叶子光滑,茎
上具有钩刺。
104 第六单元 生物的多样性及其保护林奈和双名法
自然界中的生物种类极其繁多,每种生物都有
它自己的名称。由于世界上各种语言之间差
异很大,同一种生物在不同的国家、地区、
民族往往有不同的叫法。名称不统一,常
常造成混乱,妨碍了学术交流。因此,
生物学家在很早以前就对创立世界通用
的生物命名法问题进行探索,提出了很
多命名法,但由于不太科学,没有广泛采
用。直到1768年,瑞典著名的植物学家林
奈(Carolus Linnaeus,1707—1778)在《自
然系统》这本书中,正式提出科学的生物命名
林奈
法——双名法,这个问题才得以解决。按照双名
法,每个物种的科学名称(即学名)由两部分组成,第一部分是属名,第
二部分是种加词,种加词后面还应有命名者的姓名,有时命名者的姓名可
以省略。双名法的生物学名部分均为拉丁文,并为斜体字;命名者姓名部
分为正体。例如,银杉的学名为Cathaya argyrophylla Chun et Kuang,果
蝇的学名为Drosophila melanogaster(命名者姓名省略)。
林奈从小喜爱大自然,对植物特别有兴趣,只要有机会,他就钻到
树林里去观察和采集植物。老师和同学都称他是“小植物学家”。上大学
以后,家庭的贫困给他带来很大的压力,但这丝毫也没有影响他研究植
物的热情。为采集标本,他历尽艰辛,但他从未因困难和危险而退缩。
林奈毕生从事动植物尤其是植物的分类研究,硕果累累。他一生收
集的植物标本多达14 000号,动物标本中仅贝类就有7 000号。他撰写
的《自然系统》是植物学史上划时代的著作。书中对生物所做的系统分
类,揭示了生物之间的亲缘关系,对研究生物的进化有很大帮助。
第一章 根据生物的特征进行分类 105第二章
认识生物的多样性
想一想,议一议
三北防护林早期采用的树种大多数是单一的杨树,饱受星天牛肆虐
之苦:虫灾严重地区树木被蛀得千疮百孔,树林大面积干枯死亡。为什
么树种单一的人工林比天然林容易发生严重的虫害呢?
随着人们对生物多样性(biological diversity)
通过本章学习,你将知道:
◂ 生物多样性的内涵有哪 的认识不断加深,生物多样性的内涵也更加丰富。
些? 它不仅指生物种类的多样性,还包括基因的多样性
◂ 我国的生物多样性具有 和生态系统的多样性。
哪些特点?
◂ 保护生物多样性的重要
生物种类的多样性
意义是什么?
生物到底有多少种,很难确切地统计出来。但
是,目前已知的种数就足以说明生物的种类是极其
丰富多样的。
106 第六单元 生物的多样性及其保护分析下面的资料。
类群 我国已知种数 世界已知种数 百分比/%
哺乳动物 581 4 340 13.39
鸟 1 244 8 730 14.25
爬行动物 376 6 300 5.97
两栖动物 284 4 010 7.08
鱼 3 862 22 037 17.53
蕨类植物 2 200~2 600 10 000~12 000 22
裸子植物 约240 850~940 26.7
被子植物 >30 000 >260 000 >10
资料来源:《中国生物多样性国情研究报告》,1998年出版。表中
“百分比”是我国已知种数占世界已知种数的百分比。
讨 论
❶ 在动物和植物中,除上表所列出的类群外,还有哪些类群?除动物
和植物外,你还知道哪些生物类群?
❷ 在上表中,我国哪一类生物的物种数在世界上占有的百分比最高?
哪一类相对较少?
❸ 根据你的估计,你认为是否还有很多种生物没有被发现?
从上面的资料中可以看出,地球上的生物是极
其丰富的,也是多种多样的;我国是生物种类最丰 小资料
富的国家之一。 我国是世界上现
存裸子植物种类最多
我国植物资源十分丰富,其中苔藓、蕨类和种
的国家。分布在我国
子植物的种数仅次于巴西和哥伦比亚,居世界第三
的裸子植物中,有100
位;我国是裸子植物最丰富的国家,被称为“裸 多种是我国特有的,
子植物的故乡” ;我国也是动物种类最多的国家之 如银杏、银杉、金钱
松、水杉等。
一,其中脊椎动物中的鱼、鸟和哺乳动物的种数都
位于世界前列。
在生态系统中,各种生物之间是相互依存、相
第二章 认识生物的多样性 107互制约的。生物的种类越丰富,生态系统的结构就
越复杂,抵抗外界干扰、保持自身相对稳定的能力
就越强。
基因的多样性
生物的各种特征主要是由DNA分子上的遗传
信息控制的。DNA分子很长,可以分成许多个片
段,每个片段具有特定的遗传信息,这些片段就叫
作基因。生物的细胞内有成千上万个基因。不同
种生物的基因有所不同,同种生物不同个体之间的
基因也不尽相同,每种生物都是一个丰富的基因库
(gene pool)。生物种类的多样性实质上是基因的多
样性。
我国是世界上基因多样性最丰富的国家之一,
特别是家养动物、栽培植物和野生亲缘种的基因多
样性十分丰富,为动植物的遗传育种提供了宝贵的
遗传资源。
美国曾在20世纪50年代发现栽培大豆患萎黄
病,其症状是生长受阻、植株矮缩、叶片黄化、荚
野生大豆
小粒少,严重时根系腐烂以致全株死亡。这种病害
使美国的大豆产量大幅度下降,大豆生产出现危
机。20世纪70年代末,美国科学家在我国找到了
他们所需要的野生大豆,并引进到美国,与当地品
种杂交,培育出一批抗大豆萎黄病的优良品种,挽
救了美国的大豆产业,使美国从大豆进
口国一跃成为大豆出口量最大的国家。
这是利用基因多样性改良作物品种
的一个典型实例。这方面的实例还有许
多。例如,我国科学家袁隆平院士利用
野生水稻与普通栽培水稻多次杂交,培
育出产量很高的杂交稻新品种,创造了
巨大的社会效益和经济效益(图6-2)。
图6-2 袁隆平和杂交水稻
108 第六单元 生物的多样性及其保护生态系统的多样性 ?
我国有广袤的陆地,辽阔的海洋,复杂的地形
生态系统包括哪些类
和多样的气候,从而形成了森林、草原、荒漠、湿
型?你的家乡有哪些不同
地、湖泊和海洋等多种类型的生态系统。 类型的生态系统?
综合来看,一方面,每种生物都是由一定数
量的个体组成的,这些个体的基因组成是有差别
的,它们共同构成了一个基因库;每种生物又生活
在一定的生态系统中,并且与其他的生物种类相联
系。另一方面,某种生物的数量减少或灭绝,必然
会影响它所在的生态系统;当生态系统发生剧烈变
化时,也会加速生物种类的多样性和基因多样性的
丧失。例如,当动植物种类十分丰富的热带雨林变
成单一的经济林后,林中的生物种类会迅速减少。
因此,保护生物的栖息环境,保护生态系统的多样
性,是保护生物多样性的根本措施。
练习
1. 下列有关生物多样性的叙述中,不正确的是:( )
A. 生物多样性是指生物种类的多样性;
B. 每种生物都是一个丰富的基因库;
C. 生物的种类越丰富,生态系统往往就越稳定;
D. 生态系统的多样性受到影响时,会影响生物种类的多样性和基因的多样性。
2. 我国的华南虎早已所剩无几,一直在动物园中饲养繁殖。2001年,某动物
园的华南虎生下两只小虎,眼睛是瞎的。科学家认为,这与基因有关,是
近亲繁殖的结果。分析这个事例,你对生物多样性有什么新的认识?
3. 有人说,一个物种的灭绝,可能会影响到大约30种与这种生物相关的其他
生物的生存,你认为这种说法有道理吗?
4. 问一问父母,在最近二三十年里本地的生物多样性有什么变化。
5. 有条件的话,可以访问有关的网站,了解我国生物多样性的信息。
第二章 认识生物的多样性 109第三章
保护生物的多样性
想一想,议一议
白鳍豚是我国特有的珍稀水生动物,
在长江里生存繁衍了两千多万年,然而,
近几十年来,它们的数量迅速减少。2006
年,科学家沿着长江专门调查白鳍豚的数量,结果连一头都没有发现。
一个经受了漫长岁月考验的物种,为什么会在最近这短短几十年中
走向灭绝呢?
生物多样性面临的威胁及其原因
通过本章学习,你将知道:
◂ 生物多样性面临怎样的 东部美洲狮为美洲狮亚种之一,主要分布在美
威胁?原因有哪些? 国东北部、加拿大东南部。2011年3月2日,美国
◂ 保保护护生生物物多多样样性性的的主主要要 鱼鱼类类和和野野生生动动物物管管理理局局正正式式向向世世界界宣宣布布::东东部部美美洲洲
措措施施有有哪哪些些??
狮狮已已经经灭灭绝绝。。
不不仅仅是是东东部部美美洲洲狮狮,,看看看看图图66--33,,你你就就会会明明白白,,
生生物物多多样样性性面面临临着着严严重重的的威威胁胁,,这这决决不不是是危危言言耸耸听听。。
图图66--33 北北京京南南海海子子麋麋鹿鹿苑苑中中
动动物物灭灭绝绝年年代代顺顺序序的的石石碑碑
110我国生物多样性的现状也不容乐观。
下面列出的部分珍稀动植物,有些也濒临
灭绝,有些经过保护,数量有所增长(图
6-4)。
20世纪30年代,朱鹮还广泛
分布在我国和日本等地,后
来由于森林和湿地的急剧减
少,1981年只在我国发现仅
存的7只。经过保护和繁育,
数量有较大增长。
川金丝猴主要分布在
四川、湖北、陕西等
地的高山密林中,因
长臂猿是我国仅有的类
人类的捕猎和其他干
人猿,因其前臂长而得
扰,生存的范围不断
名。主要分布于云南、
缩小。
广西、海南等地的森林
中,因森林破坏等原因,
数量急剧减少。
水杉是一种落叶乔木,树干通
直,树形优美,叶对生,扁平,
呈线形,是植物中的“活化石”,
现已在全国各地广泛栽种。
麋鹿俗称“四不像”,是一种
珙桐是一种落叶乔木,高
生活在湿地的动物。曾于1900
可达30多米,开花时,花
年在我国本土灭绝,幸有少量
序基部白色的苞片看上去
存于欧洲。我国于1985年重
像一只只白鸽,所以又称
新引入,现已繁育成功,不少
为中国鸽子树,是植物界
麋鹿已放归野外。
的“活化石”。
图6-4 我国的部分珍稀动植物
111造成生物多样性面临威胁的原因有哪些呢?
分析下列资料。
❶ 森林是全球50 % ~ 90 %的陆生生物的家园,然而目前全世界
只剩下五分之一的森林仍然保持着较大面积和相对自然的生
态系统。两千年前,我国森林覆盖率达50 %,而20世纪50年
代仅有11.81 %。
藏羚羊 ❷ 藏羚(又称藏羚羊)是我国特有物种,
是国家一级保护动物。1986年在西藏、
新疆、青海三省(自治区)的藏羚羊
栖息地,平均每平方公里有3 ~ 5头。
藏羚羊的羊绒比金子还贵重,因而它
们遭到疯狂的偷猎。到20世纪90年
代,平均每平方公里仅存0.2头。近些
年来,藏羚羊的数量虽有所增加,然而偷猎者的枪声仍然不时作响。
❸ 武汉市东湖在20世纪后期的20 ~ 30年间,由于生活
污水排入等原因,水底生活的动物从113种减到
26种,在渔获物中除放养鱼类外,原有的60多
种鱼已难见到。
❹ 凤眼蓝(俗称水葫芦)是我国100多年前从国
外引进的一种植物,曾一度用于净化污水,近
几十年来在我国部分地方出现疯长,几乎遮盖了
整个水面,使很多水生生物几乎绝迹。
水葫芦疯长
讨 论
❶ 森林大面积减少对生物多样性有哪些影响?
❷ 什么原因造成藏羚羊濒临灭绝?你身边是否有类似的现象发生?
❸ 生活污水排入水体,为什么导致水生动物种类减少?
❹ 水葫芦的疯长为什么会影响其他水生生物的生存?你生活的地方是
否有类似的事情发生?
❺ 除以上因素外,你认为还有哪些因素造成生物多样性锐减?
112 第六单元 生物的多样性及其保护图6-5 长白山自然保护区
为保护完整的温带森林生态系
保护生物多样性的主要措施
统而建立的长白山自然保护区。
为保护生物的多样性,人们把含保护对象在内
的一定面积的陆地或水体划分出来,进行保护和管
理,这就是自然保护区。建立自然保护区是保护生
物多样性最为有效的措施。我国现已建成许多保护
生态系统类型的自然保护区和保护珍稀动植物的自
然保护区(图6-5、图6-6)。
自然保护区是“天然基因库”,能够保存许多
物种和各种类型的生态系统;自然保护区是进行科
学研究的“天然实验室”,为开展生物科学研究提 图6-6 青海湖鸟岛自然保护区
为保护斑头雁、棕头鸥等鸟类
供了良好的基地;自然保护区还是“活的自然博物
及其生存环境而建立的青海湖
馆”,是向人们普及生物学知识和宣传保护生物多 鸟岛自然保护区。
样性的重要场所。
除建立自然保护区外,人们还把某些濒危物种
迁出原地,移入动物园、植物园、水族馆和濒危动
物繁育中心,进行特殊的保护和管理;还建立了濒
危物种的种质库(植物的种子库、动物的精子库
等),以保护珍贵的遗传资源(图6-7)。
为保护生物多样性,我国相继颁布了《中华人
民共和国森林法》、《中华人民共和国野生动物保护
法》和《中国自然保护纲要》等法律和文件。《中 图6-7 中国国家种质库内景
第三章 保护生物的多样性 113? 国自然保护纲要》中规定,“对于珍稀濒危物种,
要严格保护,除特殊需要经过批准,禁止一切形式
有人养殖鳄和大鲵,
的猎采和买卖。” 我国还是最先加入国际《生物多
并在市场上出售,这种行
为与野生动物保护法相抵 样性公约》的国家之一。2010年,我国颁布了《中
触吗? 国生物多样性保护战略与行动计划》(2011—2030
年)。上述法律和文件的颁布和实施,对于我国生
物多样性的保护起到了重要的作用。
练习
1. 判断下列说法是否正确。正确的画“√”,错误的画“×”。
(1)为了丰富我国的动植物资源,我国应大力引进一些外来物种。 ( )
(2)把某些濒危动物迁出原地,移入动物园,进行特殊的保护和管理,这
是保护濒危物种的最好方法。 ( )
2. 列举身边正在发生的导致生物多样性减少的行为。
3. 怎样正确理解保护生物多样性与防除鼠、蚊、蝇等有害动物之间的关系?
4. 在保护生物多样性方面,作为一名公民应当怎样做?
设计并安放人工鸟巢或饲喂器
选择一种鸟,观察其筑巢和取食行为及巢
穴的情况。用废旧材料仿照这种鸟的鸟巢制作
一个人工鸟巢或饲喂器,并把制作好的人工鸟
巢或饲喂器放置在该鸟经常活动的地方。饲喂
器要间隔一段时间就添加一次饲料。
人工鸟巢
饲喂器
114 第六单元 生物的多样性及其保护单元小结
生物多样性是珍贵的自然遗产,是人类生存和发展的基本条件之
一。由于人类活动的干扰,生物多样性面临着严重的威胁。作为一个现
代公民,应当理解每种生物都有存在的价值,保护生物多样性就是保护
人类自己,我们应当身体力行。
本单元的学习,提高了在已有知识和经验的基础上发展获取新知识
的能力,特别是收集和处理信息的能力。通过参与保护生物多样性的活
动,既能增进爱护生物的情感,又能培养自己的动手操作能力。
通过本单元的学习,对以下重要概念加深了理解。
● 对生物进行科学的分类,是认识和保护生物多样性的基础。生物
分类的依据是生物在形态结构和生理功能等方面的特征。生物分类从大
到小的等级依次是:界、门、纲、目、科、属、种。“种”是最基本的
分类单位,同种生物的亲缘关系是最密切的。
● 生物的种类多种多样;不同种生物之间的差别,归根结底是基因
组成有差别;生物栖息在一定的环境中,不同空间内的生物与环境形成
了各种生态系统,生态系统也是多种多样的。因此,生物多样性的内涵
应当包括三个层次:生物种类的多样性、基因的多样性和生态系统的多
样性。
● 生物的生存离不开一定的环境,因此,保护生物多样性,最重要
的是要保护生物的栖息环境,保护生态系统的多样性。
● 由于乱砍滥伐、乱捕滥杀、环境污染、外来物种入侵等原因,生
物多样性面临严重的威胁,保护生物多样性刻不容缓。保护生物多样性
最为有效的措施是建立自然保护区,除此之外,还可以把某些濒危物种
迁出原地,移入相应的机构进行特殊的保护。为了保护生物多样性,我
国相继颁布了一系列的法律和文件,还在全球范围内进行合作。
115后 记
本册教科书是人民教育出版社课程教材研究所生物课程教材研究开发中心
依据教育部《义务教育生物学课程标准》(2011年版)编写的,经国家基础教育
课程教材专家工作委员会2013年审查通过。
本册教科书集中反映了基础教育教科书研究与实验的成果,凝聚了参与课
改实验的教育专家、学科专家、教研人员以及一线教师的集体智慧。我们感谢
所有对教科书的编写、出版提供过帮助与支持的同仁和社会各界朋友。
本册教科书出版之前,我们通过多种渠道与教科书选用作品(包括照片、
画作)的作者进行了联系,得到了他们的大力支持。对此,我们表示衷心的感谢!
但仍有部分作者未能取得联系,恳请入选作品的作者与我们联系,以便支付稿酬。
我们真诚地希望广大教师、学生及家长在使用本册教科书的过程中提出宝
贵意见,并将这些意见和建议及时反馈给我们。让我们携起手来,共同完成义
务教育教材建设工作!
联系方式
电 话:010-58758356
电子邮箱:jcfk@pep.com.cn
人民教育出版社 课程教材研究所
生物课程教材研究开发中心
2013年5月® YIWU JIAOYU JIAOKESHU
SHENGWUXUE 义
务
八年级
教
全国优秀教材二等奖
育
教
科
义务教育教科书
上册
书
生物学 八年级 上册 封面动物/红松鼠
生
物
生物学
学
八
年
级
上
册
绿绿色色印印刷刷产产品品
初初中中封封面面生生物物学学88上上--环环境境标标 11 22002222//44//11 0099::1155